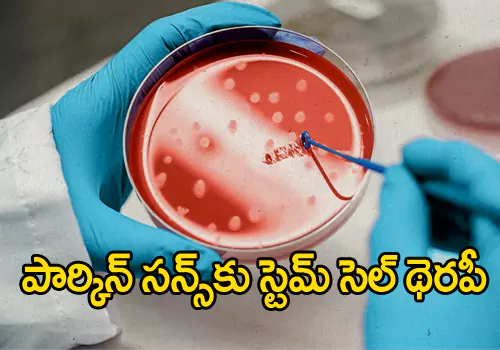

వరల్డ్ బ్రెయిన్ ట్యూమర్ డే 2౦22...
బ్రెయిన్ ట్యూమర్ ను అశ్రద్ధ చేసారో ప్రాణాలకే ప్రామాదం.మన మెదడులో కణి తలు ఉన్నాయా ప్రాణాలే పోవచ్చు.మన మెదడులో వచ్చే బ్రెయిన్ త్యుమర్స్ పై దృష్టి పెట్టాల్సిన అవస్యకతను తెలుపుతుంది.గజియా బాద్ లోని సూపర్ స్పెషాలిటి ఆసుపత్రిలో న్యూరో సర్జరీ విభాగం లో డాక్టర్ మనీష్ వైష్య మాట్లాడుతూ మన మెదడులో అసామాన్య మైన భాగాలు ఉంటాయని.అందులో అవి ఒక్కోసారి వికసిస్తాయి.అది ఆ సామాన్య మైన భాగాలు అందులో ఒక్కోసారి వాటి లక్షణాలు గుర్తించడం.సమయానికి చికిత్స అందించడం అవసరమని అన్నారు.ఒకోసారి మనకు అప్పుడప్పుడు వచ్చే త్ఘల నొప్పి పెద్దగా పట్టించుకోవాల్సిన అవసరం లేదని అయితే మీకు అదే పనిగా చాలా రోజులనుండి తీవ్రమైన తల నొప్పి ఉంటె పగలు రాత్రి అన్న తేడా లేకుండా మిమ్మల్ని నిద్ర పోనివ్వకుండా తీవ్రమైన ఇబ్బంది పెడుతూ ఉంటుంది తల తిరిగి నట్లు వాంతులు తుమ్ములు,వస్తే దానిని అశ్రద్ధ చేయకండి.మీరు తల నొప్పికి సంబందించిన మందులు వేసుకున్నా తల నొప్పి తగ్గలేదు అది ఖచ్చితంగా మీకు బ్రెయిన్ ట్యూమర్ వచ్చే అవకాసం ఉందన్న సంకేతం కావచ్చు.గత కొన్ని రోజులుగా ఈ రకమైన సమస్యలతో తీవ్ర ఇబ్బందులు ఎదుర్కున్నట్లై తే మీరు అప్రమత్తంగా ఉండండి డాక్టర్ సలహా మేరకు వెంటనే పరీక్షలు చేయించడం తప్పనిసరి.బ్రెయిన్ ట్యూమర్ ను సకాలం లో పరీక్షలు చికిత్సలు మినహా ప్రజలకు అవగాహన కల్పించడం కోసం జూన్ నెలలో వరల్డ్ బ్రెయిన్ ట్యూమర్ డే ను నిర్వహిస్తున్నారు. బ్రెయిన్ ట్యూమర్ లక్షణాలు... చికిత్సలు మినహా ప్రజలకు అవగాహన కల్పించడం కోసం బ్రెయిన్ ట్యూమర్ డే ని నిర్వహిస్తున్నారు.బ్రెయిన్ ట్యూమర్ మెదడులో ఒక కణిత లేదా ఒక పిండం మాదిరిగా కనితకు ఒక అసామాన్య మైన భాగం లో వృద్ధి చెందుతుంది. బ్రెయిన్ ట్యూమర్ వర్గీకరణ... బ్రెయిన్ ట్యూమర్ రెండురకాలుగా వర్గీకరించారు.అందులో ఒకటి క్యాన్సర్ తో కూడుకున్నది.మరొకటి క్యాన్సర్ కానిది.క్యాన్సర్ కాని ట్యూమర్ ను అది పెరిగే పద్దతుల పై ఆధార పడి ఉంటుంది.బ్రెయిన్ ట్యూమర్ రెండు శ్రేణులుగా విభజించారు.ఒకటి నేరుగా మెదడులో పెరగడం దానిని ప్రాధమిక స్థాయిలో ఉన్న బ్రెయిన్ ట్యూమర్ ఇంకొకటి శరీరం లోని మరో భాగం నుండి మెదడుకు విస్తరించడం.దీనిని సెకండరీ బ్రెయిన్ ట్యూమర్ అని అంటారు.బ్రెయిన్ ట్యూమర్ కు ప్రాధాన కారణం మన ఆలోచనలు ప్రణాళికలు దీనిపై ఆధార పడి ఉంటాయి.క్యాన్సర్ నేడు ఎంత త్వరగా విస్తరిస్తుందో అది ఎస్తానం లో ఉందొ అంటే క్యాన్సర్ ఏ స్టేజ్ లో ఉందొ తెలుసుకోవడం అవసరం. బ్రెయిన్ ట్యూమర్లు నాలుగు రకాలు... గ్రేడ్ 1 ..7 సంవత్సరాలకు పైగా పాత కాలం నాటి ట్యూమర్ గా పేర్కొన్నారు. గ్రేడ్ 2..5 నుండి 7 సంవత్సరాల కాలం నాటి ట్యూమర్. గ్రేడ్ ౩..౩ సంవత్సరాల ట్యూమర్ గా నిర్ధారించారు. గ్రేడ్ 4..9 నెలల నుండి 1 1/2 సంవత్సరం. ట్యూమర్ లక్షణాలు.. *సాధారణ మైన తల నొప్పి మెల్లగా తీవ్రంగా మారడం. *ఉదయం వేళా వచ్చే తలనొప్పికి కారణం గా నిద్రపట్టక పోవడం. *శరీరం త్వరాగా అలిసి పోవడం వాంతులు. *మీ కంటి చూపు మసక మసక గా ఉండడం లేదా ఒకవస్తువు రెండుగా కనపడడం. * బ్రెయిన్ ట్యూమర్ ఉన్న వాళ్ళ లో సహజంగా వచ్చే తల నొప్పి,లేదా తీవ్రంగా వచ్చే తల నొప్పి సరిగా నిత్దారణ కానట్లయితే సమస్యలు తప్పవు. *బ్రెయిన్ ట్యూమర్ ఉన్న వాళ్ళ లో మాట్లాడడం లో తీవ్ర సమస్యలు ఎదుర్కుంటూ ఉంటారు. *కళ్ళు తిరిగినట్లు ఉండడం ఉన్న వ్యక్తికి ఒక్కోసారి బ్రెయిన్ ట్యూమర్ ఉండక పోవచ్చు. *బ్రెయిన్ ట్యూమర్ ఉన్నవాళ్ళలో వినికిడి సమస్య రావచ్చు. బ్రెయిన్ ట్యూమర్ ఉన్న వాళ్ళు లేదా ఎవరైనా కొన్ని సమస్యల పై దృష్టి పెట్టాల్సిందే... *మీశరీరం ఫిట్ గా ఉండడం బరువు పెరగనివ్వకుండా జాగ్రత్తలు తీసుకోవాలి. *ప్రతి రోజూ ౩౦--4౦ నిమిషాల యోగా లేదా మెడిటేషన్ చెయడం తప్పనిసరి. *ఎట్టి పరిస్థితులలో ఏ రూపం లో పొగాకు వాడకం చేయాకూడదు. *మద్యం,ఎర్రటి మాంసం తినకూడదు. తక్కువ గా తినడంఆరోగ్యానికి మంచిది. *పచ్చటి ఆకు కూరలు నియమిత మొత్తము తీసుకోండి. *మీ మెదడు ప్రశాంతంగా ఉంచండి అందుకోసం సంగీతం వినండి.పుస్తకాలు చదవండి.లేదా మీకు ఇష్ట మైన పని చేయండి. సర్జరీ... బ్రెయిన్ ట్యూమర్ సర్జరీ ద్వారా ట్యూమర్ ను లేదా ఎక్కడైతే ట్యూమర్ ఉన్న భాగం తొలగించే ప్రయాత్నం చేస్తారు.ఎంతవరకూ మెదడు ట్యూమర్ లోని భాగాన్ని తొలగించాల్సి రావ.చ్చు. తొలగించినప్పటికీ లక్షణా లను తగ్గించడం లో సహకరిస్తుంది.మెదడులో ఉన్న ట్యూమర్ ను తొలగించేందుకు చేసే సర్జరీలలో ఒక్కో సారి ప్రమాదం జరగచ్చు.ఒక్కోసారి రక్త స్రావం జరిగే ప్రామాడం ఉంది.ట్యూమర్ దానిస్తానం లో ఉంటె ఎక్కడైతే ప్రమాదం ఉందొ ఇతర ప్రాత్యామ్నాయ సహాయం తీసుకుంటారు.ఏండో స్కోపిక్ స్పైన్ సర్జరీ బ్రెయిన్ ట్యూమర్ సర్జరీ చేయడం చాలా సులభం విజయ వంతంగా పూర్తి చేయావచ్చు. రేడియేషన్ తెరఫీ... రెడియెషన్ తెరఫీ లలో ట్యూమర్ వచ్చిన ప్రాంతాలాలో నష్టం కలిగించి హై ఎనర్జీ బీం లాంటి ఎక్స్ రే లేదా ప్రోటాన్స్ ను వినియోగిస్తారు. రెడి యేషన్ తెరఫీ ఎన్ని రకాలు... రేడియేషన్ వల్ల వచ్చే సైడ్ ఎఫెక్ట్స్ వస్తాయి.ఎలాంటి రేడియేషన్ ఎంత డోసేజ్ ఇవ్వాలి.ఇస్తారు.సాధారణ అయితే రెడీ యేషన్ వల్ల సైడ్ ఎఫెక్ట్స్ లో ఇన్ఫెక్షన్ వల్ల అలసట తల నొప్పి జ్ఞాపక శక్తి తగ్గిపోవడం చదవడం మెదడుపై మంట దురద వంటివి వస్తాయి. రేడియో సర్జరీ... ఇది వంశ పారం పర్యంగా చేసే సర్జరీ కాదు.ఇందులో క్యాన్సర్ తో పాటు మెదడులోని వివిధ భాగాల ను ధీ కొనాలంటే చాలా అత్యంత ప్రమాదకరమైన పరిస్థితిని సవాళ్ళను ఎదుర్కోక తప్పదు.అందుకే క్యాన్సర్ కు కీమోతేరఫీ ద్వారా ఇచ్చే మందు మాత్ర రూపం లో ఇస్తారు.లేదా ఐ వి ద్వారా అంటే ఇంటర్ వైన్ ఇంజక్షన్ ద్వారా తీసుకుంటారు.దీనిని ఎంత డోస్ ఇస్తారు.అది ట్యూమర్ పై ఆధార పది ఉంటుంది.దీనివల్ల శరీరం లో అలసట,బేజారు,వాంతులు,జుట్టు ఊడి పోవడం వంటి సమాస్యలు వస్తాయి. టార్గెట్ డ్రగ్ తెరఫీ ... టార్గెట్ డ్రగ్ తెరఫీ క్యాన్సర్ ఉన్న కణాలలో విశేషమైన అసామాన్యమైన వాటి పై దృష్టి పెడతారు.అసామాన్యమైన వాటిని బ్లాక్ చేస్తూ క్యాన్సర్ వచ్చిన కణాలాను లేదా ఆ ప్రదేశం లో ఉన్న కణాలాను పూతిగా చంపేస్తారు.బ్రెయిన్ ట్యూమర్ చికిత్స కు ప్రాత్యామ్నాయాలు ఉన్నాయి.ట్యూమర్ వాటి సైజ్ ఆకారం స్థితిని బట్టి చికిత్స ఆధార పడి ఉంటుంది.ఏ మైనా బ్రెయిన్ ట్యూమర్ ను నిర్లక్ష్యం వద్దు అప్రమత్తంగా ఉండండి.
read moreనోరో వైరస్ కలకలం...
కేరళా ను కోరోనా కొత్తవైరస్ నోరా వైరస్ వణికిస్తోంది. అది ఎంత ప్రమాద కరమో ఎలా వ్యాప్తి చెందుతుందో తెలుసుకుందాం. కరోనాతో పాటు ఇప్పుడు కేరళాలో నోరా వైరస్ ప్రమాదం పొంచిఉంది. నోరా వైరస్ కేసులు కేరళా లో కనిపిస్తున్నాయి.విజ్ ఇన్ జం లో నేడు నోరా వైరస్ రోగులను గుర్తించారు. ఈ మేరకు కేరళా ప్రభుత్వ ఆరోగ్య శాఖా మంత్రి వీణా జార్జ్ ఈ అంశం గురించి వివరించారు. నోరా వైరస్ సోకిన ఇద్దరు పిల్లలు స్థితి నిలకడ గానే ఉందని ఇప్పుడు సామ్ పుల్ తీసుకుని ఇతర పరీక్షలు నిర్వహిస్తామని ఇతర పద్దతులనుకేంద్రం మార్గ దర్సకాలకు అనుగుణంగావ్యావహరిస్తామనిప్రభుత్వం వెల్లడించింది. అలసట,వాంతులు,జ్వరం,అనుకోకుండా తీవ్రమైన నొప్పి,అదే పనిగా విరేచనాలు.ఒళ్ళు నొప్పులు,తల నొప్పి వంటి లక్షణాలు ఉంటాయని కేరళా రాష్ట్ర్రానికి చెందిన వైద్యులు వివరించారు. విజ్ ఇన్ జం లోని ఎల్ ఎం ఎస్ ఎల్ పి పాట శాలాలో బాదిత విద్యార్ధులు చదువు తున్నారని.ఆహారం విషపూరితం అయ్యిందని.డయేరియా సమస్యలతో వచ్చిన విద్యార్ధులను పరీక్షించగా నోరా వైరస్ ముందుకు వచ్చిందని తెలుస్తోంది. 2౦19 లో నోరా వైరస్ అమెరికాలో ని కొలరాడో లో వచ్చిందని.నోరా వైరస్ అత్యంత ప్రమాదకరమని హెచ్చరిస్తున్నారు . అంటు వ్యాధిగా నిర్ధారించారుఅమెరికాకు చెందిన సెంటర్ ఫర్ డిసీజ్ నియంత్రణ నివారణ సంస్థ నోరా వైరస్ ప్రజలలో త్వరగా విస్తరించే వైరస్ గా పేర్కొన్నారు. నోరా వైరస్ సంక్రమించిన వారిలో 12 గం నుండి 48 గం తరువాత దాని ప్రభావం ఉంటుందని వ్యక్తులలో డయేరియా వాంతులు అసహనం,అలసట,పోట్ట నొప్పి వంటివి ఉంటాయని ఒక్కరోజులో చాలా సార్లు వాంతులుడయేరియా తో తీవ్ర ఇబ్బందులు పడతారాని నిర్ధారించారు. నోరా వైరస్ సంక్రమించిన వారిలో వాంతులు మలము నుండి వైరస్ విస్తరించే అవకాశం ఉందని రోగిని పూర్తిగా ఐ సోలేషణ్ ఉంచాలని సూచించారు. నోరా వైరస్ ఎక్కువగా పిల్లలో కనపడుతోంది.నోరా వైరస్ విస్తరించకుండా ప్రభుత్వ యంత్రాంగం చర్యలు తీసుకోవాలని. ఇన్ఫెక్షన్ సోకిందని ఇన్ఫెక్షన్ సోకిన వారినుండి వేరొకరికి సోకే అవకాశం ఉందని నిపుణులు విశ్లేషించారు. విష ఆహారం లేదా నీరు కలుషితం అయినప్పుడు. చేయి శుభ్రంగా లేని వ్యక్తి నుండి సక్రమించవచ్చు. డయేరియా,వేరేచనాలు. వాంతులు,కడుపునొప్పి, జ్వరం,త్గలనోప్పి,ఒల్లునోప్పులు వంటి సమస్య ఉన్నపౌడు నోరా వైరస్ లక్షణం గా చెప్పవచ్చని అంటున్నారు. నోరా వైరస్ లక్షణాలు కాన పడ్డ వెంటనే అప్రమత్తంగా ఉండడం.రోగిని పూర్తిగా ఇసోలేషణ్ లోకి పంపడం ప్రధమ కర్తవ్యం. నోరా వైరస్ సోకినా వ్యక్తిని తాకినా కూర్చున్న సోకే అవకాసం ఉందన్న విషయం మీరు గ్రహించారు. .
read moreక్యాన్సర్ రోగులకు శుభవార్త....
క్యాన్సర్ కణాల నిర్వీర్యం చేయడం లో వైరస్ ఇంజెక్షన్మానవుల పై చేసిన తొలి క్లినికల్ ట్రైల్స్ లోనే అద్భుత ఫలితాలు సాధించినట్లు వెల్లడించారు. దీర్ఘకాలం గా క్యాన్సర్ తో పోరాడుతున్న రోగులకు శుభవార్త.క్యాన్సర్ కణాలను చంపేందుకు మానవులలో మొదటి సారిగా వైరస్ ను ఇంజక్ట్ చేసినట్లు తెలుస్తోంది.ఇందుకోసం నిర్వహిస్తున్న క్లినికల్ ట్రైల్స్ లో వివిదరకాల క్యాన్సార్లను పూర్తిగా నిర్మూలించే అంశం పై క్లినికల్ ట్రైల్స్ ద్వారాశాస్త్రజ్ఞులు మదింపు చేస్తున్నట్లు తెలిపారు. వైరస్ ఇంజక్ట్ చేసిన తరువాత తీసుకోవాల్సిన జాగ్రత్తలు.తట్టు కో గలిగే శక్తి ఉందా లేదా.మానవులలో ఉన్న క్యాన్సర్ కణాలను చంపుతుందా లేదా వైరస్ వల్ల వచ్చే ఇన్ఫెక్షన్ లు పై అధ్యయనం చేయాల్సి ఉంది.నూతన తెరఫీ ని వ్యాక్సీనియా గా నామ కారణం చేసారు.క్యాన్సర్ కణాల వ్యాప్తిని నిరోధించడం.క్యాన్సర్ సైజును తగ్గించడం వంటి పరిణామాలను పశువుల పై చేసిన పరిశోదనలో వైరస్ ను తక్కువ మోతాదులో వాడినట్లు తెలిపారు. నూతన తెరఫీ ద్వారా క్యాన్సర్ కణాల వ వ్యాప్తిని నిరోధించడం.క్యాన్సర్ కణాలు లక్ష్యంగా క్యాన్సర్ ఎడ్వాన్స్ స్టేజిలో సైతం నియంత్రిన్చాగల సామర్ధ్యం తెరఫీ సాధిస్తుందా లేదా అన్న అంశం పై మరిన్ని పరిశోదనలు చేయాల్సి ఉంది. పేస్ వన్ క్లినికల్ ట్రైల్స్... యాంటి క్యాన్సర్ డ్రగ్ ప్రయోగం నిర్వహించారు.దీనిని సి ఎల్ ౩౩ హెచ్ ఎన్ ఐ ఎస్ లేదా వ్యాక్సినా గా నామకరణం చేసారు.ఈ ప్రయోగం లో పాల్గొన్న తొలి వ్యక్తి అంకలిస్టిక్ వైరస్ ఇన్ సె క్ట్ క్యాన్సర్ కణాలను ను చంపేస్తుందని అది ఆరోగ్యానికి ప్రమాదం లేదన్న విషయాన్ని ప్రయోగం నిరూపించింది.అని నిపుణులు వెల్లడించారు. వ్యాక్సీనియా ఏమిటి?... వ్యాక్సీనియా జనటికల్ గా స్మాల్ పాక్స్ వైరస్ ద్వారా ఎక్కువ సంఖ్యలో ఉన్న క్యాన్సర్ కణాలను నివారించడం లో ల్యాబొరేటరీ లో చేసిన ప్రయోగం దోహదపడిందని. యు ఎస్ కు చెందిన సిటి హోప్స్ క్యాన్సర్ రీసెర్చ్ బ్రౌల్మేట్ ఇన్స్టిట్యుట్, ఆస్ట్రేలియాకు చెందిన ఇమ్యుజీన్,బయోటెక్ కం పేనీ సంయుక్తంగా నిర్వహిస్తున్న నావల్ వైరస్ క్యాన్సర్ రోగాలకు,ఆంకలిక్ వైరస్ కనితలు ,కణాల సైజు ను తగ్గిస్తుందని అత్యంత నమ్మకంగా నిర్వహించాగాలిగా మని నిర్వా హాకులు సిటి వాప్ కు చెందిన సర్జరీ విభాగం అధ్యక్షుడు.డాక్టర్ యమన్ ఫాగ్ సిఎఫ్ ౩౩ వ్యాక్సినా ద్వారా అన్నిరకాల క్యాన్సర్ లక్ష్యంగా తయారు చేసినట్లు వివరించారు.తెరఫి వైరస్ లు కొత్తవి కావడం విశేషం. ఇమ్యుజిన్ సి ఇఓ లేస్లె చాంగ్ మాట్లాడుతూ క్యాన్సర్ తెరఫీ లో విప్లవాత్మక మార్పులకు ప్రయత్నం చేస్తున్నట్లు తెలిపారు. తెర ఫీ వల్ల సంతృప్తి చెందామని. క్యాన్సర్ తో బాధపడే వారి జీవితం పెంచగలిగామని అన్ని క్యాన్సర్లకు తెరఫీ పనిచేసే లక్ష్యం గా పనిచేస్తున్నట్లు చెప్పారు. అంకోలిటిక్ వైరేస్లు... అంకా లెటిక్ వైరస్ ప్రకృతిలో సహజంగానే ఉంటాయని జనిటిక్ గా ప్రత్యేకంగా ఎంపిక చేసిన పరిశోదన చేసిన వైరస్ వల్ల క్యాన్సర్ కణాలు ఇన్ఫెక్ట్ అయిన క్యాన్సర్ కణాలు కణి తలను ను వైరస్ చంపేస్తుందని.కొన్ని సందర్భాలాలో కణితలు పగిలినప్పుడు ట్యూమర్ లో ప్రోటీన్ లేదా యాంటి జన్స్ విడు దల చేస్తుంది. ఇమ్యూన్ సిస్టం ఒక ఫారన్ బాడీగా గుర్తిస్తుంది.ఇమ్యూన్ రెసిస్టన్స్ యాంటి జన్స్ ట్యూమర్ కణాలు చనిపోతాయాని ద్రువీకరించారని శాస్త్రజ్ఞులు పేర్కొన్నారు. ఈ వైరస్ వల్ల అదనంగా రోగనిరోదక శక్తి సామర్ధ్యం పెరిగినట్లు గుర్తించారు. కణి తలు జ్ఞాపక శక్తి,యాన్టిజన్స్ క్యాన్సర్ మరణాలు రాకుండా సంరక్షిస్తుంది.అంకలిక్ చిన్నడోస్ కణితలకు వ్యతిరేకంగా పనిచేస్తుంది. వైరస్ క్యాన్సర్ కణాల వృద్ధిని నిరోదిస్తుంది. ఆరోగ్యంగా ఉన్న క్యాన్సర్ కణాలు ప్రోటీన్ రేసేప్టర్ రోగనిరోధక శక్తిని మెటా స్టేసైజ్ కణాలు చనిపోకుండా రక్షిస్తుంది.అంకలైటిక్ వైరస్ క్యాన్సర్ కణాలు ప్రోటీన్ లక్ష్యంగా పనిచేస్తుంది. డాక్టర్ ఫాంగ్ గుర్తించిన అంశాలు ఏమిటి?... క్యాన్సర్ కణాలు లక్షణాలు వాటి పనితీరు.ఆశ్చర్యాని కలిగిస్తుంది.అన్నారు.క్యాన్సర్ కణాలు కీమోతేరఫీ,రేడియేషన్,చికిత్సలు వైరస్ ను పెంచుతాయని.వైరస్ ఒక సాధనంగా ఉపయోగపడతాయని ఫాంగ్ అభిప్రాయ పడ్డారు. వ్యాక్సీనియా లక్ష్యం క్యాన్సర్ కణాలే... సి ఎఫ్౩౩ హెచ్ ఎన్ ఐ ఎస్ వ్యాక్సీనియా ను వృద్ది చేసారు.ఆధునీకరించిన వ్యాక్సీనియా స్మాల్ పాక్స్ వైరస్ దీనిని సి ఎఫ్౩౩ హెచ్ ఎన్ ఐ ఎస్ ట్యూమర్ సేల్స్ పై పనిచేసే విధంగా అందుకు తగిన సామర్ధ్యం ఆధునీక రించిన వ్యాక్సీనియా వైరస్ ప్రోటీన్ ట్యూమర్ పోదియంగా పిలుస్తారు.ట్యూమర్ సేల్స్ వైరస్ వల్ల ఇన్ఫెక్ట్ అయి రేడియం యాక్టివిటీ అప్రోడిన్ అప్ చెక్ శరీరానికి అయో డి న్ ట్రాక్ వైరస్ పంపిణీ చేయడం ద్వారా ప్రభావ వంతంగా పనిచేస్తుందని అన్న్తున్నారు నిపుణులు. ఆంకో లిక్ వైరస్ జంతువులలో పెరిగిందని కాంబినేషన్ తెరఫీ కన్నా ప్రభావ వంతంగా ఉంటుందని నిపుణులు దృ వీకరించారు. ఇతర ఇమ్యునో తెరఫీ ల కన్నా ఇంకి బెటర్స్ కార్ట్ తేరఫీలు సి ఎఫ్ ౩౩ వ్యాక్సినేషన్ ఫ్లాట్ ఫారం త్వరగా వృ ద్ది చెందుతుందని వివిధ రకాల కాంబినేషన్ లో క్లినికల్ గా మరిన్ని క్లినికల్ గా మరిన్ని పరీక్షలు నిర్వహించాల్సిన అవసరం ఉంది. క్యాన్సర్ చికిత్సలో... ఇతర ఇమ్యునో తెర ఫీల కన్నా ప్రభావ వంతమైనదని నిపుణులు తేల్చారు. తెరఫీ ప్రభావం, పని తీరు మెరుగుగా ఉంటుందని ఆశా భావం వ్యక్త్గం చేసారు.క్యాన్సర్ తెరఫీలో కార్ టి సెల్ తెరఫీ 1౦ సంవత్సరాలలో సత్ఫలితాలు ఉన్నాయని నిపుణులు పేర్కొన్నారు. క్యాన్సర్ లో కొవ్వు పదార్ధాలు ఉన్న ఆహారానికి సంబంధం ఉందా? క్యాన్సర్ వల్ల కొన్ని అపోహాలు.
read moreవణికిస్తున్న క్రిమియన్ కాంగో హెమరేజిక్ ఫీవర్
కోరోనా వైరస్ అనేకారూపలలో తన విశ్వరూపాన్ని చూపిస్తోంది టమాటా పాక్స్,మంకీ పాక్స్ నేడు 21 దేశాల్లో తన ప్రతపాని చూపిస్తోంది. యూరోప్ దేశాలలో విస్తరిస్తున్న మంకీ పాక్స్ నేడు ప్రాణాల కు హానికలగక పోవడం కొంత మేర ఉపసమనం కలిగిస్తుందని నిపుణులు భావిస్తున్నారు. కోరోనా తరువాత ప్రాణాంతక మైన కాంగో హేమరేజ్ ఫీవర్ ప్రాణాలు తీసేస్తోందని సమాచారం.ఈ మేరకు కాంగో హేమరేజ్ ఫీవర్ జ్వరం ముక్కుద్వారా లేదా శరీరం లోని ఇతర భాగాలలో ఎక్కడైనా రక్త స్రావం అయినా ఈ రోగులు మరణిస్తున్నారని తెలుస్తోంది. ప్రపంచం లో కోరోనా ఇంకా విషం చిమ్ముతూనే ఉంది.ఇప్పుడు మధ్య పశ్చిమ ఆశియా దేశాలలో ముఖ్యంగా ఇరాక్ లో ఈ మధ్య కాలం లో ఒక కొత్త రోగం త్వరగా విస్తరిస్తోంది. కాంగో హెమరేజిక్ ఫీవర్లక్షణాలు... దీనిలక్షణాలు చూసినప్పుడు రోగికి తీవ్ర జ్వరం,ముక్కు నుండి రక్తం కారడం. ఈ వ్యాదిద్వారా రోగుల ముక్కునుండి రక్తస్రావం కారణంగా మరణిస్తున్నారని తెలుస్తోంది. మీడియాలో వస్తున్నసమాచారం ప్రకారం ఈ వ్యాధిబారిన పడ్డ దాదాపు 19 మంది మరణించారు. ఈ రోగం విస్తరించిన గ్రామీణ ప్రాంతాలాలో ఆరోగ్య కార్యకర్తలు పిపి ఇ కిట్లను ధరించి రక్తశ్రావం తో వస్తున్న జ్వర పీడితులకు క్రిమియన్ కాంగో హెమరేజిక్ ఫెఅవేర్ అని పేరు పెట్టారు. జంతువుల ద్వారా మానవులకు త్వరగా విస్తరిస్తోమ్దని ఇరాక్ ప్రభుత్వ వర్గాలు వెల్లడించాయి. వ్యాధి విస్తరణ... క్రిమియన్ కాంగో హేమరేజ్ వ్యాధి కీటకాలు కాటు వేయడం వల్ల విస్తరిస్తుంది.ప్రపంచ ఆరోగ్య సంస్థ ఇచ్చిన సమాచారం మేరకు జంతువులకు క్రిమియన్ హేమరేజ్ వైరస్ జంతువుకు సోకినా,ఈ వ్యాధి సోకిన జంతువు మాంసము తిన్న ఈ వ్యాధి బారిన పడతారని రోగి శరీరం లోపల బయట రక్త్గా స్రావం జరుగుతుంది. దక్షిణ ఇరాక్ లో విజ్రుం భిస్తున్న కేసులు ఇరాక్ ఆరోగ్య శాఖ అధికారులు వివరాల ప్రకారం గతసంవత్సరం లో ఈ వ్యాధి వేళ్ళ మీద లెక్కించ దగిన స్థాయిలో మాత్రమే ఉన్నాయని ఇప్పుడు ఈ వ్యాధి దున్నపోతులు,ఆవులు,మేకల ద్వారా వ్యాపిస్తుందని నిపుణులు అంటున్నారు.
read moreప్రపంచ పొగాకు వ్యతిరేక దినోత్సవం 2౦22...
ఆరోగ్యంతో పాటు వాతావరణాన్ని కలుషితం చేస్తున్న పొగాకుకు వ్యతిరేకంగా పోరాడాల్సిన అవసరం ఉందని మహావీర్ డెంటల్ రీసెర్చ్ ఆసుపత్రికి చెందినప్రముఖ దంత వైద్యులు డాక్టర్ బి చంద్రకాంత్ అన్నారు.డాక్టర్ చంద్రకాంత్ తెలుగు వన్ హెల్త్ తో మాట్లాడుతూ పొగాకు ఉత్పత్తులు సేవించడం వల్ల ప్రమాదకరమైన రోగాలు వస్తున్నాయని అన్నారు.ప్రజల అనారోగ్యానికి ప్రత్యక్షంగా పరోక్షం గా ఆరోగ్యం పై తీవ్ర ప్రభావం చూపుతోందని అన్నారు.అందుకే మీరు ఆరోగ్యంగా ఉండాలంటే పొగాకుకు దూరంగా ఉండాలనిడాక్టర్ చంద్రకాంత్ సూచించారు.దాదాపు ఈ మధ్యకాలం లో ఖైనీ,గుట్కా,పొగాకు ఉత్పత్తుల సేవనం పెరిగిపోవడం తో నోటి క్యాన్సర్ బారిన పడుతున్న వారి సంఖ్య గణనీయం గా పెరిగిందని అన్నారు.ఈ మేరకు మహావీర్ డెంటల్ సెంటర్ లో దంత సంరక్షణ తోపాటు మ్యక్సిలో ఫేషియల్ సర్జరీ ద్వారా నోటి క్యాన్సర్ ను గుర్తించి శస్త్రచికిత్సలు చేశామని చంద్రకాంత్ వివరించారు. భారత్ లో దాదాపు 27 కోట్ల ప్తజలు పొగాకు సేవిస్తున్నారని దీంతో పాటు దాదాపు 12 కోట్ల ప్రజలు సిగరెట్,చుట్ట,బీడీ వంటివి సేవిస్తున్నారని డాక్టర్ చంద్రకాంత్ పేర్కొన్నారు.భారత దేశంలో ప్రతిఏటా 12 లక్షల ప్రజలు మరణిస్తున్నారని గ్లోబల్ ఎడల్ట్ టొబాకో సర్వే 2౦16 -2౦ 17 రిపోర్ట్ ఆధారంగా భారత్ లో పొగాకు సేవిస్తున్న వారిలో 18.7 సంవత్సరాల వారు ఉన్నారు.మహిళల తో పోలిస్తే తక్కువ వయస్సు ఉన్న పురుషులు పొగాకు సేవించడం దురదృష్ట కరమనిడాక్టర్ చంద్రకాంత్ అన్నారు.ప్రపంచం లో ప్రతిఎటా సిగరెట్ ఉత్పదనల కోసం 6౦ కోట్ల చెట్లు నరికేస్తున్నారని 22 లీటర్ల నీరు వృదా చేస్తున్నారని పొగతాగడం వల్ల 8.4 కోట్ల టన్నుల కార్బన్ డై ఆక్సైడ్ ఉత్పత్తి చేస్తున్నారని అన్నారు.దీనివల్ల వాతావరణానికి తీవ్ర నష్టం కలుగుతోందని అన్నారు.2౦22 సంవత్సరం లో ప్రపంచ పొగాకు వ్యతిరేక దినోత్సవం యొక్క లక్ష్యం నినాదం పర్యావరణ పరిరక్షనే అని పిలుపు నిచ్చారు. నిబందనల అమలు వైఫల్యం... 16 వ శతాబ్దం లో అక్బర్ శాసన కాలం నాటినుండే మొదటి సారి పోర్చుగల్ దేశస్తులు పొగాకు తీసుకోచ్చారు.జహంగీర్ శాసన కాలం లో పొగాకు నియంత్రించేందుకు పొగాకు పై పన్ను విధించారు. అయినప్పటికీ కొన్ని వందల స్మ్వత్సరాలు గడిచిన పొగాకు వ్యాపారం మూడు చుట్టలు ఆరు బీడిల సాగిపోతోంది పొగాకు వ్యాపారం నియంత్రణకు ఉక్కుపాదం మోపాలేక పోయారు.ఆరోగ్యం వాతావరణం రెండూ ప్రమాదం లో పడ్డాయి. పొగాకు పలు రకాల క్యాన్సర్ కు కారణం అవుతోంది.. ప్రస్తుత పరిస్థితులలో అత్యధిక భాగం రోగాలకు కారణం పోగాకే దీనికారణంగా 25 రకాల రోగాలు దాదాపు 4౦ రకాల క్యాన్సర్లు వస్తాయని డాక్టర్ చంద్రకాంత్ అన్నారు.క్యాన్సర్ ప్రభావితమయ్యే వాటిలో నోరు,ముఖం,గొంతు,ప్రోస్టేట్,పొట్టలో క్యాన్సర్ ప్రధాన మైనవి.దీనితోపాటుబ్రెయిన్ ట్యూమర్ కూడా పొగాకు ప్రయోగం కారణంగా నే అని డాక్టర్ చంద్రకాంత్ స్పష్టం చేసారు.పొగాకు నుండి 5౦౦ హానికారక గ్యాస్ 7౦౦౦ రకాల రసాయన పదార్ధాలుఉత్పత్తి అవుతాయి.ఇందులో నికోటిన్ టన్ ప్రాధాన మైనవి.సిగరెట్ తో పోల్చినప్పుడు బీడీ తాగడం అత్యంత హానికారకం తేల్చారు.మనదేశం లో మహిళల ఆపేక్ష మేరకు పురుషులు పోగతాగుతున్నారని.ఎవరైనా పొగాకు కు లో బీడీ సిగరెట్ తగారంటే వారి ఊపిరి తిత్తులలో ౩౦%చేరుతుందని.దాదాపు దగ్గర దగ్గర వాతావరణం లో 7౦ % ఉంటుందని దానివల్ల కుటుంబ సభ్యులు పొగతాగే వారి పక్కనకూర్చోవడం వల్ల పోగ తాలూకు ప్రభావం ఉంటుందని అన్నారు అలాగే తాగేవారి కన్నా ఆపక్కన కూర్చున్న వారికి పై తీవ్ర ప్రభావం చూపుతుంది.దీనిని పెసివ్ స్మోకేర్స్ గా పేర్కొన్నారు. ఊపిరి తిత్తులు పాడై అనుకోకుండా మరణిస్తారు ... ప్రపంచవ్యాప్తంగా వస్తున్న మరణాలు5౦% ఉన్నాయని వాటికీ కారణం పోగాకే అని నిర్ధారించారు.పొగాకు నేరుగా తీసుకోవడం వల్ల నేరుగా ఊపిరి తిత్తులపై ప్రభావం చూపుతుందని రక్త ప్రసారం,బిపి,ఊపిరి తీసుకోలేక పోవడం .అదే పనిగా పొగతాగడం వల్ల బ్రోంకైటిస్ ,గుండెపోటు,నపుంసకత్వం మైగ్రైన్,జుట్టుతేల్ల బడడం,లేదా జుట్టు రాలిపోవడంఇతర సమస్యలు ఉన్నాయని డాక్టర్ చంద్రకాంత్ పేర్కొన్నారు.పొగాకు పండిస్తున్న దేశాలలో భారత్ దే ప్రధమ స్థానం.ప్రపంచం లో పొగాకు ఉత్పత్తి ప్రయోగాలలో రెండవ స్థానం.లో మనమే ఉన్నాం.దీనిప్రభావం చూసిన తరువాత ఉత్పత్తి,అమ్మకం పై నిషేధం విధించాలి దీనిపై పర్ల మెంట్ లో పొగాకు నిషేధం చేసేందుకు చట్టం చేయాలన్న అంశం పై అనేక చర్చలు జరిగాయి. పొగాకు వ్యవసాయం చేస్తున్న వారిలో దాదాపు ౩ కోట్ల ప్రజలకు ఉపాది లభిస్తుందని అంచనా.భారాత దేశ ఆర్ధిక మంత్రిత్వ శాఖ 2౦15 -2౦16 గణాంకాల ప్రకారం.పొగాకు ఉత్పత్తుల ద్వారా ౩5,6౦౦ కోట్లు రూపాయలు అర్జిస్తుందని ఆర్ధిక నిపుణులు అంచనా వేస్తున్నారు.అయినప్పటికీ 1,౦4,5౦౦ కోట్ల పొగాకు వల్ల దుష్ప్రభావం వల్ల వస్తున్న పొగాకు నివారణకు ఖర్చుచేస్తున్నారని పొగాకు వల్లే తీవ్ర నష్టం కలుగుతోందన్నది వాస్తవం అందుకే పోగాకు ఉత్పత్తులు అమ్మకం పూర్తిగా నియమ నిబంధనలు అమలు చేయాలి.నిషేధం విధించాలి.అటు ఆరోగ్యం ఇటు వాతావరణానికి కి మేలు చేస్తుంది పిల్లల పై తీవ్రప్రభావం... మహిళలు గర్భవతులుగా ఉన్నప్పుడు పొగాకు తాగడం వల్ల తీవ్రప్రభావం చూపుతుంది.దీనిపై అప్పుడే పుట్టిన శిశువు పై ప్రభావం చూపుతుంది.ఈ కారణంగానే శిశువు బరువు తగ్గ వచ్చు.గర్భావస్తలో ఉన్నప్పుడే మరణించవచ్చు.పుట్టుక నుంచే శిశువు వివిదరకాల అనారోగ్య సమస్యల బారిన పడుతూ ఉంటారు. ఆరోగ్యం తో ఆటలాడ కండి... పొగాకు బీడీ సిగరెట్,గుట్కా,ఖైనీ,వంటి వాటికి కరోనా సంక్రమించే అవకాసం ఉంది కోరోనా మహమ్మారిని దృష్టిలో ఉంచుకుని పొగాకు తాగడం నుండి మిమ్మల్ని మీరు రక్షించుకోండి.కోరోనా విస్తరించడానికి అధిక సంఖ్యలో తీవ్ర అనారోగ్యం పలవ్వడానికి పొగాకు సేవించడం నుండి దూరంగా ఉండండి.ఇంటి నుండి బయటికి వెళ్ళే టప్పుడు మాస్క్ ను తప్పని సరిగా వాడండి.ఇది శ్వాస నాళాల ద్వారా విస్తరించే రోగం మిమ్మల్ని మీరు రక్షించుకునేందుకు వాయు కాలుష్యం నుండి రక్షిస్తుంది.పొగాకు సేవించడం ఆరోగ్యానికి హానికరం అని మీకు తెలిసినా పొగాకును విడి చి పెట్టేందుకుమీరు మీడాక్టర్ సలహా తీసుకోండి.నికోటిన్ లేని నికోటిన్ రేప్లసే మెంట్ తెరఫీ సహకరిస్తుంది.మీరు యోగా ప్రాణాయామం,పొగాకు బీడీ,సిగరెట్ వదలడం లో సహాయ పడుతుంది.మీరు పొగాకు విదిపెట్టాలని మీరు భావించినప్పుడు కొన్ని యాప్స్ మీకు సహక రిస్తాయి.
read moreవణికిస్తున్న మంకీ ఫాక్స్... ఇప్పటికే 21 దేశాలకు విస్తరణ
ప్రపంచ వ్యాప్తంగా మంకీ పాక్స్ పెరుగుతున్నాయని సి డి సి వెల్లడించింది. ప్రతిరోజూ 2౦౦ కేసులు నమోదు అవుతున్నట్లు సమాచారం.యూరోపియన్ సెంటర్ ఫర్ డిసీజ్ ప్రివెంక్షన్ కంట్రోల్ సెంటర్ నివేదిక అందించింది. ప్రపంచ వ్యాప్త్గంగా 2౦19 కేసులు ఉన్నట్లు నిర్ధారించింది.యుఎస్ లో 9 కేసులు,యు కే లో 71 కేసులు ప్రపంచవ్యాప్త్గంగా 226 కేసులు నమోదు అయినట్లు వెల్లడించింది. ఎవరికైనా దద్దుర్లు లేదా చారలు వారి శరీరం పై ఉంటె ప్రత్యేకంగా ఎవరికైనా న్యు సెక్సువల్ పార్టనర్ ఉంటె వారు నియంత్రించుకోవాలి. స్థానికంగా ఉన్న ఆరోగ్య కార్యకర్తలను సంప్రదించాలి.యు కే ఆరోగ్య ప్రాధాన సలహాదారు మాట్లాడుతూ యౌరోపియన్ యునియన్ లోని 12 దేశాలు స్పెయిన్ లో 51 కేసులు పోర్చుగల్ లో ౩7 కేసులు నమోదు అయ్యాయని అనివేదికలో పేర్కొన్నారు. యురప్ లోని యువకులలో 118 కేసులు గుర్తించామని అధికారులు తెలిపారు.ఎవరైతే గే బైసేక్సు వల్ పురుషులు సెక్స్ చేస్తారో వాళ్ళలో మంకీ పాక్స్ ఉందని గుర్తించారు. చాలా కేసులలో రోగులకు దద్దుర్లకు వైద్య చికిత్స అందిస్తున్నారు.ముఖ్యంగా జన నెంద్రియాలలో దాని ద్వారానే వైరస్ బిందువులు విస్తరించి ఉండవచ్చు. మే నెలకు ముందు ఎండమిక్ గా భావించారు.కొన్ని దేశాలలో కరోనా వైరస్ తగ్గుముఖం పట్టిందని ఇటీవల కాలం లో ఇతర దేశాలకు ప్రయాణం సాగించిన వారిలో మంకీ పాక్స్ వస్తోందని గుర్తించారు. ఒక చైన్ పద్దతిలో యురప్ లో విస్తరించడం తొలిసారి అని నిపుణులు ఆశ్చర్యం వ్యక్తం చేసారు.పశ్చిమ మధ్య ఆఫ్రికాలో వీటి మూలాలు ఎపిడమా లజీ లో ఉన్నాయా లేదా అన్నది తెలియాల్సి ఉందని ఆనివేదికలో పేర్కొన్నారు. ఒక పక్క కోరోనా వ్యాధి చివరిదశ కు చేరిందని ఎండమిక్ గా చెప్తున్నప్పటికీ యురోపియన్ సి డి సి నివేదికలో కేసులు నమోదు కావడం పట్ల తీవ్ర ఆందోళన వ్యక్తం చేసింది.అయితే ఇప్పటికీ మరణాలు నమోదు కాక పోవడం పట్ల కొంత ఉపసమనం కలిగించిందని లేకుంటే మంకీ పాక్స్ విజ్రుంభిస్తే తట్టుకోవడం అసాధ్యమని నిపుణులు అభిప్రాయ పడ్డారు. ప్రపంచ వ్యాప్తంగా ఉన్న ప్రజా ఆరోగ్య శాఖ అధికారులు చాలా పోజిటివ్ కేసులు అందులో అనుమానించదగ్గ శ్యాంపుల్స్ లో జనటిక్ సీక్వెన్సింగ్ కు పంపారు.కెనడాలో 11 కొలంబియా లో అకేసులు 16 కు చేరాయని నిపుణులు పేర్కొన్నారు. రానున్న రోజులలో మరిన్ని కేసులు నిర్ధారించే అవకాశాలు ఉన్నాయి.అధికారికంగా ఆరోగ్య శాఖ ఒకప్రకటనలో వెల్లడించింది. స్మాల్ పాక్స్ కు వేసే వ్యాక్సిన్ 85% ప్రభావ వంతం గా పనిచేస్తుందని సి డి సి వద్ద ఉన్న వివరాల ప్రకారం బివేరియన్ నార్తిక్ పెద్దగా గుర్తింపు లేని సంస్త్ఘతో ఒప్పందం కుదుర్చుకున్నట్లు తెలిపారు. వ్యాక్సిన్ కొనుగోలు చేసేందుకు వివిదరకాల ఉత్పాదక సంస్తలతో మాట్లాడుతున్నట్లు ఆయాదేశాల ప్రతినిధులు స్పష్టం చేసిబట్లు అనివేదికలో పేర్కొన్నారు. ప్రస్తుతం అమెరికాలోని వ్యక్తికి మంకి పాక్స్ తో తీవ్ర ఇబ్బంది పడుతున్న వ్యక్తి కోసం రెండు డోసుల వ్యాక్సిన్ స్తేటర్గిక్ నేషనల్ స్టాక్ ఫైట్ ద్వారా మంకీ పాక్స్ నుండి రక్షించేందుకు ప్రయత్నం చేస్తున్నారు. కెనడా,స్పెయిన్,యుకే లో విస్త్య్హరించకుండా వ్యాక్సిన్లు వేసేందుకు ఆయాదేశాలు సన్నద్ధం అవుతున్నాయి. మంకీ పాక్స్ వైరస్ ప్రమాదకరమా ? మంకి పాక్స్ నుంచి మనల్ని మనం ఎలా సంరక్షించు కోవాలి.చికిత్స పద్దతుల గురించి తెలుసుకుందాం.... మంకి పాక్స్ వైరస్ చర్మం,కళ్ళు,ముఖం మధ్య ప్రాంతం లో ప్రవేశిస్తుంది.మంకి పాక్స్ వైరస్ సంక్రమించిన జంతువు కు సోకడం వల్ల,దాని రక్తం శరీరం పై అంటినా ఆ మాంసం మనం తిన్న మంకి పాక్స్ వస్తుంది. కరోనా నుండి దేశాలకు ప్రపంచానికి ఇప్పటికీ ముప్పు తగ్గలేదు ఈ మధ్యలో ఇది చాలదు అన్నట్లు మంకి పాక్స్ వ్యాపిస్తోంది. ప్రపంచ ఆరోగ్య సంస్థ ఇచ్చిన ఒక రిపోర్ట్ ఆధారం గా ప్రపంచం లో 19 దేశాలలో మంకి పాక్స్ వ్యాపించిందని 1౩1 మంది వ్యాధి బారిన పడ్డారని తెలిపారు. మంకి పాక్స్ ఇప్పుడు ఇటలి, స్వీడన్,స్పెయిన్,పోర్చుగల్,అమెరిక,కెనడా,యుకె,వరకు చేరింది.ఈ వైరస్ శాస్త్రజ్ఞుల ను సైత్గం ఆలోచనలో పడేసింది. మంకి పాక్స్ అంటే ఏమిటి ? సీనియర్ ఫార్మాస్యుటికల్ ఏనాలసిస్ట్ సేమ్ ఫజేరీ అభిప్రాయం ప్రకారం మంకి పాక్స్ ,చికన్ పాక్స్,స్మాల్ పాక్స్,లాంటి ఆర్తో ఫోక్స్ వైరస్ గా చెప్తున్నారు. అయితే మరణాల విషయం లో స్మాల్ పాక్స్ కన్నా ప్రభావం తక్కువగానే ఉంటుందని పెద్ద సమ స్యాత్మకం కాదని ఈ వ్యాధికి ఉన్నపేరు దృష్ట్యా ఇది కోతుల ద్వారా వ్యాపిస్తుందనేది అవాస్తవమని.అది వ్యాపించే వైరస్ కాదని తేల్చారు. మంకి వైరస్ ఎలా వ్యాపిస్తుంది.? మంకి పాక్స్ వైరస్ చర్మం,కళ్ళు ముక్కు లేదా ముఖం ద్వారా శరీరం లోకి ప్రవేశిస్తుంది.ఆయా జంతువులకు వ్యాధి సోకిన జంతువు కరిచినా,లేదా రక్తం శరీరం పై పడినా తాకినా సంక్రమిస్తుంది.మంకి పాక్స్ సంక్రమించిన జంతువు మాంసం తిన్న మంకి పాక్స్ వస్తుంది. మంకి పాక్స్ కు చికిత్స ఏమిటి?/మంకి పాక్స్ కి చికిత్స లేదా? మంకి పాక్స్ కి సమయానికి చేచక్ టీకా ద్వారా మంకి పాక్స్ ను నివారించేందుకు 85%ప్రభావ వంతం గా పనిచేస్తుంది.ముకే ఆరోగ్య రక్షణ శాఖ ఏజన్సీ వ్యాక్సిన్ ప్రభావం వంతం కాదని తెలిపింది.యునివర్సిటి ఆఫ్ నాటింగ్ హం మాలిక్యులర్ వైరాలాజీ ప్రొఫెసర్ జునదన్ బాల్ మాట్లాడుతూ మంకిపాక్స్ సోకినా రోగి 5౦ లో ఒక్కరికి మాత్రమే సోకిందని దీనిద్వారా మనకు తెలిసింది ఏమిటి?మంకి పాక్స్ పెద్దగా వ్యాప్తి చెందడని తెలుస్తోందని నిపుణులు పేర్కొన్నారు. మంకి పాక్స్ పట్ల అప్రమత్తత అవసరం... మంకి పాక్స్ తో బాధ పడుతున్న కొన్ని రోజుల తరువాత వ్యాక్సిన్ తీసుకోవడం ద్వారా కొంత మేర రక్షించుకోవచ్చు.కివిడ్ కన్నా కొన్ని వైరస్ లు సంక్రమించడం లేదని కాబట్టి భయపడాల్సింది లేదని కాని త్వరగా విస్తరించదు.మనం సంక్రమించిన వ్యక్తి నుండి దూరం పాటించడం వల్ల దాని నుండి రక్షించుకోవచ్చు.
read moreయాంటీ ఆక్సిడెంట్స్ అంటే ఏమిటి... ఎలా సహకరిస్తాయి
మన శరీరం లో కొన్ని రసాయనాలు పోరాడతాయి. మీ కణాలలో దీనిని అక్సిడేషన్ ముఖ్య కారణం. కొన్ని మొక్కల ఆధారం గా లభించే ఆహారం కాని మీ శరీరం కొన్ని రకాల పోషకాల వల్ల ఆరోగ్యంగా ఉంటారు.అది ఆక్సిడెంట్స్ అని చెప్పవచ్చు. అసలు ఆక్సిడెంట్ అంటే ఏమిటి?... మనశరీరం లో ఉండే రాసాయనాలు మీ కణాలను కాపాడేందుకు పోరాడతాయి.దీనిని ఆక్సిడేషన్ అని పిలుస్తారు.దీనికి ఆధారం కొన్ని రకాల ఆకు కూరలుఅవి మీకు విటమిన్ సి డి లను అందిస్తాయి. బీటా కెరటన్,మినరల్స్ సెలనియం మాంగనీస్,ప్లాంట్ న్యుట్రియంట్స్ మరియు రసాయనాలు.ఫ్లావో నాయిడ్స్ ముఖ్యంగా పల్లీలు పోటి సినట్స్, పిటో ఈస్ట్రో జన్స్ ,కూడా యాంటి ఆక్సిడెంట్స్ అని అంటారు. యాంటి ఆక్సిడెంట్స్ ఏమి చేస్తాయి... ఒక్కొకటి వివిధ రకాలుగా పనిచేస్త్గాయి.అన్ని కలిసి సమూహంగా ప్రీ రాడికల్స్ పై పోరాడతాయి.ఈ రసాయనాలను ఆక్సిడేషన్ తయారు చేస్తాయి. అది మీకణాలను నాశనం చేస్తాయి.వాటిలో జనటిక్ మెటీరియల్ ఉండచ్చు.అందులో మన శరీరాన్ని ప్రీ రాడికల్స్ ఆహారాన్ని తయారు చేస్తాయి.ఎండ,టాక్సిన్స్ అందులోనూ పొగలు ప్రకృతి కాలుష్యం ఆల్కాహాల్ వంటివి యాంటి అక్సిడెంట్స్ ప్రీ రాడికల్స్ ను ఆపాలి అవి తయారయ్యే ముందు నిండిపోవాలి లేదా విచ్చిత్తి కావాలి.లేదా అది హానికారకం కావు.అని నిపుణులు అంటున్నారు. విటమిన్ ఇ... ఆక్సిడెంట్స్ ఫ్యాట్స్ లో నిల్వ ఉంటాయి.వాటిని ఫ్యాట్ సాలబుల్ అవి ఫ్రీ రాడికల్స్ తో పోరాడు తాయి.మీ శరీరంలో ఉన్న కొవ్వు కణాలు గోడల పై దాడి చేస్తుంది.ఎల్ డి ఎల్ కొలస్ట్రాల్ ఆర్టిప్ లో చేరతాయి.అది మీ గుండె సంబంధిత సమస్యలు వ్యాధులు దారి తీస్తుంది. విటమిన్ ఇ ని ఎలాతీసుకోవాలి.. పప్పులు,కూరగాయలు,ఆలివ్ ఆయిల్,సన్ ఫ్లవర్ఆయిల్ ,కనోల్,ఆకు కూరలు,కొన్ని నట్స్ ద్వారా విటమిన్ ఇ పొందవచ్చు. విటమిన్ సి.... దీనిని అస్కి బిక్ యాసిడ్ అది నీటిలో నిల్వ ఉంటుంది.దీనిని వాటర్ సోలబుల్ దీని ని వాడడం వల్ల పొట్టలో వచ్చే క్యాన్సర్, లేదా ఊపిరి తిత్తులలో వచ్చే క్యాన్సర్ ,ఆహారం అరుగుదల తదితరాలకు విటమిన్ సి ఉపయోగ పడుతుంది.పచ్చటి ఆకుకూరలు టమాటాలు సిట్రస్ ఫ్రూట్స్,ఆరంజ్,సంత్ర,ద్రాక్ష పచ్చి ఆహారాలు వండడం ద్వారా అందులో ఉండే ఇతర విటమిన్స్ నాశనం అవుతాయి. బీట్ కెరోటిన్... అవి ఫ్యాట్స్ ను అందిస్తాయి.అవిపసుపు రంగులో,పసుపచ్చ,ఆరంజ్ ,ఎర్రటి రంగులో ఉండే ఆహారం పళ్ళు మన శరీరం రేటినట్ రంగులోకి మారుతుంది.అది మీకు సప్లిమెంట్స్ రూపం లో తీసుకుంటే ప్రమాదం కావచ్చు.ఆహారం ద్వారా తీసుకోవడం మంచిది అది కొన్నిరకాల పండ్లు పప్పులు క్యారట్స్ ,పాల కూర ఇతర ఆకుకూరలలో లభిస్తుంది. లైకో పెన్... కెరోట నైడ్ వల్ల మనశరీరంలో వచ్చే ప్రోస్టేట్,ఊపిరి తిత్తుల వక్షోజాలక్యాన్సర్ నుండి రక్షిస్తుంది. లైకో పెన్ ను తీసుకోవడం ఎలా వండిన తయారు చేసిన ట మాటాల నుండి లభిస్తుంది.పాస్తాలో మీరు తీసుకునే మారినా సాస్, టమాటాలను వేడి చేయడం ద్వారా శరీరానికి చాలా సులభంగా లైకో పెన్ కలిసి పోతుంది.దీనిలో ఆలివ్ ఆయిల్ వేయడం ద్వారా కొవ్వు చేరి శరీరానికి విటమిన్లను అందిస్తుంది. సీలినియం... సెలీనియం మనకు నీటిలో భూమిలో కనిపిస్తుంది.మనకు దీనిద్వారా లభించే మినరల్స్ థైరాయిడ్ కు పనిచేస్తాయి.వీటిపై చేసిన పరిశోదనలో సెలీనియం ప్రత్యేకంగా ఎక్కువగా తీసుకుంటే ఊపిరి తిత్తుల క్యాన్సర్ లేదా పెద్దపేగు లో వచ్చే క్యాన్సర్,ప్రోస్టేట్ క్యాన్సర్ వంటివి వస్తాయి.వీటిని సప్లిమెంట్ రూపం లో తీసుకుంటే సమస్యలు తప్పవు.అది ఒక్కోసారి అన్నవాహిక సమస్యలకు కారణం అవుతుంది.దీనికారణం గా జుట్టు,గోళ్ళు కోల్పోక తప్పదు. సిలినియం తీ సుకోవాలంటే పాప్పులు, ఉల్లిపాయాలు,వెల్లుల్లి, సోయాబీన్స్,సముద్రపు ఆహారం,మాంసం,లివర్ ద్వారా సిలినియం పొందవచ్చు. ఫ్లావో నాయిడ్స్... శాస్త్రజ్ఞులకు 4,౦౦౦ రకాలకు పైగా ఉన్న యాంటి ఆక్సిడెంట్స్ పండ్లు కూరగాయలలో యాంటి ఆక్సిడెంట్ ఉన్నట్లు గుర్తించారు.కాగా ప్రతి మొక్కలో రకరకాల వాసనలలో యాంటి ఆక్సిడెంట్ ఉంటాయని గుర్తించారు.అవి మీ గుండె సంబంధిత సమస్యలకు క్యాన్సర్ ఆర్తరైటిస్,జ్ఞాపక శక్తి కోల్పోవడం స్ట్రోక్,ఇన్ఫెక్షన్ ఇంఫ్లామేషణ్ నుండి రక్షిస్తాయ ఒమేగా ౩... ఒమేగా 6 ఫ్యాంటి యాసిడ్స్ ఒమేగా౩ గుండె సంబంధిత సమస్య నుండి రక్షణ కల్పిస్తుంది. స్ట్రోక్ అర్తరైటిస్ క్యాట్రాక్ట్,క్యాన్సర్,నివారణలో సహాయ పడగలవు. ఒమేగా 6 ఎస్ ఎక్జిమా,సోరియాసిస్,ఆస్టియో ప్రోరోసిస్,వంటి వాటిని నియంత్రించడం లో సహకరిస్తుంది. మీ శరీరం లో అత్యవసరమైన ఫ్యాటీ యాసిడ్స్ ను తయారు చేయాలేదు.ఇంఫ్లామేషన్ ను నిరోదిస్తుంది అందుకే చాలామంది అమెరికన్లు ఒమేగా 6 లేదా ఒమేగా ౩ లేదా మాంసకృత్తులు ఉంచేందుకు ఒమేగా 6 ను ఆహారం లో తీసుకుంటారు. అయితే ఒమేగా౩ ని తక్కువగా ను వినియోగిస్తారు.మనకు ఒమేగా6 ఒక భాగం కాగా ఒమేగా ౩ సప్లిమెంట్ మాత్రమే అది ఆహారం ద్వారా లభిస్తే మరీ మంచిది. ఒమేగా మనకు ఎలా లభిస్తుంది... వాల్ నెట్స్,సాల్మన్,ట్యూన్,సార్టి నిస్ లో ఒమేగా ౩ ఒమేగా6 కూరగాయలు,నూనెలు, నట్స్,ఫౌల్ట్రీ లలో ఒమేగా6 ,ఒమేగా ౩ లభిస్తుంది. మీరు ఒక మాత్ర మాత్రమే వేస్తే సరిపోదు... దీర్ఘ కాలం పాటు జరిపిన పరిశోదనలో వేయికి పైగా ప్రజలతో నిర్వహించిన పరిశోదన.యాంటి అక్సిడెంట్స్ మాత్ర ద్వారా తీసుకుంటే అనారోగ్యం తగ్గదని ఎవరైతే గుండె సమస్యలు క్యాన్సర్,క్యాట్రాక్ట్,ఒకే స్థాయిలో ఉండడానికి వయసుతో సంబంధం లేదని లేదా వయస్సు రీత్యా వచ్చిన అరుగుదల యాంటీ ఆక్సిడెంట్స్ సప్లిమెంట్స్ మెల్లగా అభివృద్ధి చేస్తాయి.కంటికి సంబందించిన సమస్యలకు చాలా ఆలస్యంగా తీసుకుంటారు. అతిగా యాంటి అక్సిడెంట్స్ తీసుకోవడం మంచిదేనా?... చలారకాల యాంటి ఆక్సిడెంట్స్ ఆహారం ద్వారా తీసుకోవడం లేదా సప్లిమెంట్ ఫాం లో అతిగా తీసుకోవడం వల్ల మీకు తాగే అలవాటు ఉంటె ఊపిరి తిత్తుల క్యాన్సర్ వచ్చే అవకాశం ఉంది.విటమిన్ ఇ వల్ల ప్రోస్టేట్ క్యాన్సర్,స్ట్రోక్ వచ్చే అవకాశం ఈ ఉత్పత్తులు కొన్ని మార్గాలు మాత్రమే అని మీరు వాడె అన్ని విషయాల గురించి పూర్తిగా వివరించండి.మరో మందు రూపం లో ఇవ్వరు. కాబట్టి యాంటి ఆక్సిడెంట్స్ శరీరానికి ఉపయోగము అతిగా వాడితే ప్రమాదము అన్న విషయం మీరు గ్రహించాలి.
read moreపార్కిన్ సన్స్ కు స్టెమ్ సెల్ థెరపీ...
పార్కిన్ సన్స్ కు స్టెమ్ సెల్ తెరఫీ చికిత్స ద్వారా లక్షణాలను రివర్స్ చేయవచ్చుఅంటున్నారు శాస్త్రజ్ఞులు. పార్కిన్ సన్స్ వ్యాధి మెదడులోని న్యురాన్స్ మెదడు మధ్య భాగం లో నాశనం చేస్తాయి.మెదడులోని డిపో మైన్ న్యూరో ట్రాన్స్ మీటర్ ద్వారా కదలికలను నియంత్రించ వచ్చు. ఒక నూతన పరిశోదన లో శాస్త్రజ్ఞులు నాన్ న్యూరోసెల్స్ ను మార్పు చెందడం ద్వారా న్యురా న్స్ ను తిరిగి పని చేయించ వచ్చు.న్యురాన్ ను ఇప్పటికే ఎలుకల పై న్యూరాన్లు గ్రాఫ్ట్ చేయగా అవి రివర్స్ అయ్యాయి.పార్కిన్ సన్స్ ను కొంతమేర రివర్స్ చేయవచ్చని వివరించారు. ప్రపంచం లో 1౦,౦౦౦ మిలియన్ల ప్రజలు పార్కిన్ సన్స్ వ్యాధితో బాధ పడుతున్న వారికి ఇది ఊరట నిస్తుందని అంటున్నారు శాస్త్రజ్ఞులు. పార్కిన్ సన్స్ ఫౌండేషన్ అందించిన వివరాల ప్రకారం పార్కిన్ సన్స్ కు ఎల్ డోపా మందు బ్రెయిన్ లో ఉండే డో పామైన్ కొన్ని లక్షణాలను ఎలివేట్ చేస్తుంది.ఏది ఏ మైనప్పటికి ఈ మందు ను అదే పనిగా వాడితే డిస్కి నీషియా అంటే శరీరం లో తన ప్రమేయం లేకుండానే కదలికలు వస్తాయి. న్యూరో డీ జనరేటివ్ డి జార్దర్ లో ఒక ముందడుగుగా శాస్త్రవేత్తలు భావిస్తారు. పార్కిన్ సన్స్ మధ్య మెదడులో న్యురాన్స్ ను గుర్తించి నాశనం చేస్తుంది.న్యూరాన్లు డో పామైన్ ను న్యూరో ట్రాన్స్ మీటర్ వల్ల కదలికలలో కీలక పాత్ర పోషిస్తుంది. మెదడులో డోపమైన్ లోపం వల్ల పార్కిన్ సన్స్ లక్షణాలు వస్తాయి.దీనికారణం గా నే ట్రీమర్స్, స్టిఫ్ నెస్,వినికిడి శక్తి తగ్గడం. ఈకారణం గానే సమన్వయ లోపం వస్తుంది. శాస్త్రజ్ఞులు అవిశ్రాంతం గా చేస్తున్న పరిశోదనలు ప్రభావ వంతమైన చికిత్స అందించేందుకు దోహదం చేస్తుంది.మరింత సమాచారం సేకరించ వచ్చని తెలుస్తోంది. ఒక నూతన పరిశోదన లో రీ జన రేటివ్ మెడిసిన్ జర్నల్ లో ప్రచురించారు.ముఖ్యంగా పార్కిన్ సన్స్ లో మోటార్ సిస్టం ను రివర్స్ చేయడం కోసం ఫ్లూరి పొంటేంట్ స్టెమ్ సేల్స్ ను ఎలుకల లో ఇంప్లాంట్ చేయడం ద్వారా న్యురాన్స్ మార్చడం ద్వారా వ్యాధిని నాశనం చేస్తాయని పేర్కొన్నారు. ఐ పి ఎస్ సి సేల్స్ కు చికిత్స డో పామైన్ ఉత్పత్తి ద్వారా న్యురాన్స్ ను పనిచేయించడం ద్వారాడాక్టర్ జేమ్స్ బెక్ సీనియర్ వైస్ ప్రెసిడెంట్ చీఫ్ సైన్స్ ఆఫీసర్ పార్కిన్ సన్స్ ఫెడరేషన్ స్వచ్చంద సంస్థ పార్కిన్ సన్స్ తో ఇబ్బంది పడే వారిజీవితాలాను వృద్ధి చేసేందుకు కృషిచేస్తున్నారు. పార్కిన్ సన్స్ నివారణకు ఆధునిక పరిశోధన జరుపుతున్నారు. ఎలుకలలో సేల్స్ ను బ్రెయిన్ కు ఇంప్లాంట్ చేసినప్పుడు ఒక పరిశోదన లో ఫైబర్ బ్రాంచ్ కనక్ట్ చేయడం ద్వారా మెదడులో డోపమైన్ ఉత్పత్తి చేస్తుంది. నియమ నిబంధనల అమలు... పార్కిన్ సన్స్ పై చేస్తున్న పరిశోధనలకు కొన్ని నియమనిబంధనలు పరిమితుల ను విజయ వంతం గా అమలు చేసారు.ముజ్హ్యంగా న్యూరో సేల్స్ కానివాటిని న్యురాన్స్ గా పనిచేయించడం అంటే కణాలు ఉత్తమ మైన వని డాక్టర్ జెఫ్రీ కోర్టోవర్ డైరెక్టర్ ఏ ఎస్ యు బి ఏ ఎన్ ఎన్ ఇ ర్ న్యూరో డీ జన రేటివ్ రీ సెర్చ్ సెంటర్ ఆరిజోనా స్టేట్ యునివర్సిటి లోనిపుణులు తెలిపారు. కణాలను పూర్తిగా 17 నుండి24 రోజుల వరకు కల్చర్ చేసారు.కణాల అభివృ ద్ది ఉత్తమ ఫలితాలు అందిస్తుందని డాక్టర్ బెక్ తెలిపారు. మొత్తం మీద ఈ పరిశోదనలో17 మంది పాల్గొన్నారు.17 రోజులపాటు వారికి చికిత్స కల్చర్ చేసినట్లైతే వారిలో ఉన్న వివిదరకాల సమస్యలు మార్పులు వర్గీకరించి ఉత్తమం గా పని చేయవచ్చని.డాక్టర్ కోర్ట్ వర్ అభిప్రాయ పడ్డారు. ఈ కణాలను ఎలుకల్ మెదడులోకి క్రాఫ్ట్ చేసినప్పుడు వాటికికణాలు త్వరగా పెరిగాయని డాక్టర్ కోర్టోవర్ అన్నారు. కణాలను మామూలుగా వాటి వాటి మెదడులో ఇంప్లాంట్ చేయడం ద్వారా వారిలో దీర్ఘకాలం పాటు ఉండే శక్తి ఉంటుందని డాక్టర్ కొడోవర్వివరించారు.తిరిగి అవికోలుకోవాలంటే డోస్ పైనే ఆధార పడి ఉంటుందని నిపుణులు విశ్లేషిస్తున్నారు. ఒక పరిశోదనలో పరిశోధకులు ఐ పిఎస్ సి ఇచ్చిన డోస్ లో ప్రభావం ఎలాఉంటుంది పరిశీలించలేదని డాక్టర్ కోరోవర్ అన్నారు. న్యూరో సర్జన్లకు మాత్రమే ఎన్ని సేల్స్ ఇంప్లాంట్ చేయవచ్చో తెలుస్తుందనిఅనారు. కొన్ని కణాలు బాగానే ఉన్నా అవి తగ్గించబడి దీర్ఘకాలం గా కొన్ని సైడ్ ఎఫెక్ట్స్ ఉండవచ్చునని మీరు చూడాలనుకున్న ప్రభావం మీరు చూడవచ్చని.నిపుణులు స్పష్టం చేసారు. కొన్ని కణాలు ఇంప్లాంట్ చేస్తే ఉదాహరణకు 5,౦౦౦ వేస్తే పనిచేసేందుకు రికవరీ ఉండవని డాక్టర్ కోరోవర్ వివరించారు.1౦,౦౦౦ కణాలు ఆపైన కణాలు ఇంప్లాంట్ చేసినా 4 నెలలో పూర్తిగా పనిచేయడం కోలుకోవడం ఎలుకలలో కనిపించిందని పేర్కొన్నారు. చికిత్స చాలా సురక్షితమని పేర్కొన్నారు.అయితే మెదడులో ఎటువంటి ట్యూమర్లు రాలేదని చూడలేదని కొన్ని కణాలు మాత్రమే వేరు పడ్డాయని పెద్దగా ఇబ్బంది లేదని వీటిని అమలు చేయవచ్చని తెలిపారు. ఇక హ్యూమన్ ట్రైల్స్ మిగిలి ఉన్నాయి.... మేము చేసిన పరిశోదన చాలా నమ్మకం కలిగించిందని.ఇక రోగులపై నేరుగా ట్రయల్స్ నిర్వహిస్తామని అన్నారు.క్లినికల్ ట్రైల్స్ కూడా డాక్టర్ కొడోవర్ ఇన్వెస్టి గేషణ్ పరిశోదన2౦2౩ వరకు కొనసాగుతుందని ప్రజలలో వ్యక్తిగతంగా పార్కిన్సన్స్ లో రక రకాల మార్పులు వస్తున్నాయని జన్యు పరమైన మార్పులను గమనించ నున్నట్లు.తెలిపారు. వ్యక్తి గతంగా పార్కిన్ సన్స్ అనుభవాలు డోపమైన్ విధానం తిరిగిపోవడం మోటార్ పని చేయక పోవడం వంటివి పార్కిన్ సన్స్ దిమ్నీషియా వృద్ది చెందడం వల్ల ఖచ్చితంగా సేల్స్ మార్పిడి ప్రణాళిక బద్ధమైన నిర్ణయాలు తీసుకోవాల్సి ఉటుంది.అప్పుడు మాత్రమే పరిశోదన ఉపయోగ పడుతుందని తెలిపారు. పరిశోదన విజయవంత మైతే పెద్దస్థాయిలో పరిశోనలు ట్రైల్స్ ప్రజలతో నిర్వహించాల్సి ఉంటుంది.జంతువుల పై చేసిన పరిశోదనలు ఎల్లప్పుడూ వాటిని తర్జుమా చేయలేమని మనుషులపై చేసే ప్రయోగాలు మాత్రం నిత్యం మార్చడం సాధ్యం కాదు.
read moreకరోనాతో పాటు పొంచి ఉన్న మరో ప్రమాదం...
పది సంవత్సరాల తరువాత పార్కిన్ సన్స్ ప్రమాదం రెండు రెట్లు... పార్కిన్ సన్స్ వ్యాధి మరింత ప్రమాదకారి అని నిపుణులు హెచ్చరిస్తున్నారు. కోరోనా సంక్రమించిన వారి పై చేసిన పరిశోదనలో ఈ విషయం శాస్త్రజ్ఞులు వెల్లడించారు. ప్రపంచ వ్యాప్త్గంగా పార్కిన్సన్స్ వ్యాధితో 2% ప్రజలు దీనిబారిన పడుతున్నారు.వాస్తవానికి 55 సంవత్సరాల వయస్సులో ఉన్నవారికి మాత్రమే వచ్చే అవకాశం ఉందని నిపుణులు వైద్యులు నిపుణులు అభిప్రాయ పడ్డారు. కోరోనా సోకిన వ్యక్తి పై వీటి ప్రభావం ఎలా ఉంటుంది.అసలు కోరోనాకు ఎవరు బాధ్యులుఅన్న అంశం పై పరిశోదనలు జరుతున్నాయి. ఒక పరిశోదనలో కోరోనా మహమ్మారి కారణ మైన సార్క్ కోవిడ్ 2 వైరస్ పార్కిన్ సన్స్ వ్యాధిని పెంచడం లో సహకరిస్తుంది. పార్కిస్ సన్స్ న్యూరో డీ జనరేటివ్ సమస్య ఇందులో వ్యక్తి శరీరం వణుకుతూ ఉంటుంది.నడవడం లేదా మెడ నిలపలేకపోవడం వంటి సమస్యలు వస్తూ ఉంటాయి.తిరిగినప్పుడు శరీరం బ్యాలెన్స్ కోల్పోతారు.పరిశోధకులు దీనిపై మరిన్ని పరిశోదనలు జరగాల్సి ఉందని వివరాలు పూర్తిగా రాబట్టడం అవసరం ఉందని నిపుణులు అభిప్రాయ పడ్డారు.ఈ వ్యాదినివరణకు ఇప్పటినుంచే సన్నద్ధం కావాలని నిపుణులు హెచ్చరిస్తున్నారు. పార్కిన్ సన్స్ కోరోనా మహమ్మారి కి కారణ మైన సార్క్ కోవిడ్ పాత్ర పై ఎలుకల పై చేసిన ఒక పరిశోదన లో పార్కిన్ సన్స్ ఒక మూవ్ మెంట్ డి జార్దర్ జర్నల్ లో ఈ అంశాన్ని ప్రచురించారు. కోరోనా వైరస్ ను ఎలుకల మెదడు నరాలు టాక్సిన్ కు విరుద్ధంగా పనిచేయకుండా చేస్తాయి.పార్కిన్ సన్స్ వ్యాధికి కారణం గా పేర్కొన్నారు. టాక్సిన్స్ ప్రభావం వల్ల మెదడులో ని భాగాల కు తీవ్ర విఘాతం కలిగిస్తాయని గమనించారు. నిపుణుల అభిప్రాయం ప్రకారం ప్రపంచవ్యాప్తంగా పార్కిన్ సన్స్ వ్యాధి వల్ల 2% ప్రజలు దీని బారిన పడ్డారని నిపుణులు గమనించారు. కాగా ఈ వ్యాధి 55 సంవత్సరాల వయస్సులో వచ్చే అవకాశం ఎక్కువగా ఉన్నందున అది మెదడుపై ఎలాంటి ప్రభావం చూపుతుంది. దీని గురించిన సమాచారం తెలుసుకోవడం అవసరమని దీనివల్ల భవిష్యత్తులో దీనిని ఎదుర్కునేందుకు ముందు చూపుతో వ్యవహరించాల్సిన అవసరం ఉందని నిపుణులు సూచించారు. పరిశోధకుల వువరాల ప్రకారం వైరస్ ప్రభావం పై చేసిన నూత్గన పరిశోదన మొదటి ప్రమాణాల పై ఆధార పడిఉంది.ఇందులో వైరస్ మెదడులోని నరాలకు తీవ్ర నష్టం కలిగిస్తాయని నిపుణులు స్పష్టం చేసారు. ఇన్ఫ్లూ ఎంజా 1౦ సంవత్సరాల తరువాత పార్కిన్ సన్స్ ప్రమాదం రెండు రెట్లు... 2౦౦ 9 లో ఈ విధంగా ఇంఫ్లూ ఎంజా మహమ్మారి ప్రపంచ వ్యాప్త్గంగా వివిధ దేశాలలో చాలా మంది ని తమ గుప్పెట్లో కి తీసుకుంది. ఆ తరువాత ఈ వ్యాధి పై చేసిన చేసిన పరిశోదనలు చేసిన పరిశోదన సుర్తించాల్సిన అంశం ఏమిటి అంటే ఇంఫ్లూ ఎంజా మహమ్మారి వ్యాప్తి వెనుక ఎన్1 ఎన్1 వైరస్ ఉంది?పరిశోధకులు ఈ వైరస్ ను ఎలుకలకు సంక్రమింప చేసినప్పుడు వాటికి పర్కిన్సన్స్ లక్షణాలు ఉత్పన్నం చేసే ఎం పి టి పి టాక్సిన్ పట్ల అధిక ప్రభావం చూపడం లో ఈ వైరస్ మానవులపై చేసిన పరిశోదనలో ఇంఫ్లూ ఎంజా వచ్చిన 1౦ సంవత్సరాల తరువాత పార్కిన్ సన్స్ ప్రమాదం రెండు రెట్లు ఉంటుంది.
read moreకలవర పెడుతున్న ఒ మైక్రాన్ సబ్ వేరియంట్లు
కోవిడ్ 19 తగ్గిపోయిందని ఇక రాదని దాదాపు ప్రపంచమాన వాళి ఇక ఊపిరి పీల్చుకుంటుంది. సౌత్ ఆఫ్రికాలో ఇటీవలే కొత్త సబ్ వేరియంట్స్ ను కనుగొన్నారు.బి ఏ 4,బి ఏ 5 సబ్ వేరియంట్స్ ఇతర దేశాలాలో విస్తరిస్తోంది. యు కే,యు ఎస్ లలో ప్రస్తుత పరిస్థితిని గమనించవచ్చని నిపుణులు అంటున్నారు. ఈ అంశాల పై యుఎస్ యుకె నిపుణులు సాక్ష్యా ధరాలతో కూడిన అంశాల పై పరిశోదన జరుపు తున్నారు. వెస్టన్ కేప్ మెట్రో అత్యవసర సేవల విభాగం వ్యాక్సిన్ అంబు లెన్స్ వ్యా క్సినేషన్ ఈవెంట్ నిర్వహించారు.ఆల్ఫా,బీటా గామా డెల్టా ఒమేక్రాన్ వంటి వేరియంట్స్ ఒకటి తరువాత మరొక వేరియంట్స్ పుట్టుకోస్తు న్నాయి. కంటి మీద కునుకు లేకుండా చేస్తున్నాయి. ఒమైక్రాన్ వేరియంట్స్ బి ఏ4,బి ఏ5 ఇటీవలే సౌత్ ఆఫ్రికా లో గుర్తించారు.సౌత్ ఆఫ్రికా ఇతరదేశాలలో కోవిడ్19. పరీక్షలు నిర్వహిస్తున్నారు. దక్షిణ ఆఫ్రికాలో పోజిటివ్ పరీక్షలు నిర్వహిస్తున్నారు.బిఏ4,బిఏ5 పూర్తిగా ప్రభావం చూపిస్తుంది.నేషనల్ ఇన్స్టిట్యుట్ ఆఫ్ క్లినికల్ డిసీజ్ దక్షిణ ఆఫ్రికాలో బిఏ 4,బిఏ 5 ఒమైక్రాన్ వైరస్ లు మ్యుటేట్ కావడాన్ని గమనించవచ్చు. శాస్త్రజ్ఞులు బిఏ 4,ను జనవరి 1౦-2౦ 22 న కనుగొన్నారు.సౌత్ ఆఫ్రికాలో విస్తరించిన విషయాన్ని గమనించారు అందులో నిర్వహించిన పరీక్షలలో ౩5% పోజిటివ్ కాగా బిఏ 5ఫిబ్రవరిలో 2౦%కేసులు దక్షణ ఆఫ్రికాలో గుర్తించారు. స్పైక్ ప్రోటీన్ మ్యుటేషన్... పైన పేర్కొన్న ఒమైక్రాన్ బి ఏ2 యు కే లో తీవ్ర ప్రభావం చూపుతోంది.కాంటినెంటల్ యురప్ ,యుఎస్ లో విస్తరిస్తున్నట్లు సమాచారం.బి ఏ4,బి ఏ5 మ్యుటేట్ కావడాన్ని గుర్తించారు.ఇతర ప్రాంతాలలో సైతం వైరస్ మార్పు చెందడాన్ని గమనించవచ్చు. కోవిడ్19 వేరియంట్స్ లో సబ్ వేరియంట్స్ రూపాంతరం చెందుతూ కనిపిచడాన్ని శాస్త్రజ్ఞులు గుర్తించారు. కొత్త కొత్త వేరియంట్స్ గా మారడాన్ని శాస్త్రజ్ఞులు గమ నించారు.వీటిని డ్రిఫ్ట్ వేరియంట్స్ ఒకే కుటుంబానికి చెందినవి గా భావించ వచ్చు. వేరియంట్స్ ఎక్కడ ఉన్నాయి... ఇప్పటికే బిఏ4 ,బిఏ5,వేరియంట్స్ చాలా దేశాలలో గుర్తించారు.యు కే హెల్త్ సెక్యూరిటీ సంస్థ ఏప్రిల్ 22 నాటికి బిఏ4 ఆస్ట్రియా,యుకే, యుఎస్,డెన్మార్క్,బెల్జియం,ఇజ్రాయిల్,జర్మనీ,ఇటలి,కెనడ, ఫ్రాన్స్,నెదర్లాండ్స్, ఆస్ట్రేలియా,స్విట్జర్ల్యాండ్,బోట్స్వానా,లో విస్తరిస్తోందని నిపుణులు పేర్కొన్నారు. బిఏ5 పోర్చుగల్, జర్మనీ,యుకే,యు ఎస్,డెన్మార్క్,ఫ్రాన్స్,ఆస్ట్రేలియా,బెల్జియం హాంగ్ కాంగ్ ఆస్ట్రేలియా, కెనడా,ఇస్తాంబుల్,నార్వే పాకిస్తాన్,స్పెయిన్,స్విట్జర్ ల్యాండ్,పోజిటివ్ పరీక్షలలో డబ్ల్యు హెచ్ఓ మే 4 నాటికి తీవ్రంగా మారడం పట్ల డబ్ల్యు హెచ్ ఓ తీవ్ర ఆందోళన వ్యక్తం చేసింది.చాలా దేశాలలో వైరస్ వస్తుందా లేదా వచ్చినా కంటికి కనబడ కుండా తీవ్ర ప్రభావం చూపడం ఆందోళన కలిగిస్తుంది.వైరస్ మ్యుటేట్ కావడం పై తీవ్ర ఆందోళన వ్యక్తం చేస్తున్నారు.ఆతరువాత ఏ వైరస్ వస్తుందో అంచనా వేయడం కష్టసాధ్యంగా మారిందని నిపుణులు విశ్లేషిస్తున్నారు. మే12 నాటికి యురప్,సిడిసి వివరాల ప్రకారం బిఏ4 బిఏ5 వేరియంట్లు గురించి మాట్లాడుతూ పోర్చుగల్ లో కోవిడ్ పెరగడం పై పోర్చ్గుగీస్ ఆరోగ్య అత్యవసర పరిస్థితి ప్రకటించింది.మే 8 నాటికి బిఏ5 ౩7%కేసులు పెరగడం ఆందోళన కలిగిస్తోందని ప్రభుత్వం ప్రకటించింది.బిఏ4,బిఏ5 త్వరగా వ్యాప్తి చెందుతుందని సి డి సి వెల్లడించింది. ఇటీవల భారత్ లో కేసుల సంఖ్య గణనీయం గా పెరగక పోయినా బిఏ4 బిఏ5 త్వరా విస్తరిస్తున్నకారణం గా అప్రమత్తం గా ఉండాలని నిపుణులు హెచ్చరిస్తునారు.
read moreవరల్డ్ ఎయిడ్స్ వ్యాక్సిన్ డే...
హెచ్ ఐ వి ఇన్ఫెక్షన్ నుండి విముక్తి కావాలంటే సురక్షితంగా ఉండాలన్నా కొన్ని అంశాలాను గుర్తుంచు కోవాలి.ఎయిడ్స్ ఇన్ఫెక్షన్ నుంచి మనల్ని మనం ఎలా రక్షించుకోవచ్చు.అన్నది నేడు సాధ్యమేనా అన్నది ఒక ప్రశ్న.వరల్డ్ ఎయిడ్స్ వ్యాక్సిన్ డే ను ప్రతిఏటా మే నెలలో నిర్వహిస్తూ ఉంటారు.ప్రాణాంతక మైన రోగం నుండి రక్షింప బడాలంటే టీకా వేయించుకోవడం అత్యవసరం.అలాగే హెచ్ ఐ వి నుండి ఎలారక్షణ పొందాలి. అన్న విషయం తెలుసుకోవడం అవసరం.హెచ్ ఐ వి హ్యూమన్ ఇమ్యునో డి ఫిషియన్సీవైరస్ కారణం గా ఎక్వైర్డ్ ఇమ్యునో డి ఫిషియన్సిసిండ్రోం.అంటే ఎయిడ్స్ భయంకర మైన వ్యాధి.అది ప్రతియేటా లక్షల సంఖ్యలో మరణాలకు కారణం అవుతోంది.ఈ సమయం లో ఎయిడ్స్ నుంచి రక్షించుకోవాలంటేఆరోజుల్లో వ్యాక్సిన్లు లేవు.అయితే ప్రతియేటా ప్రపంచ ఎయిడ్స్ వ్యాక్సిన్ డే.హెచ్ ఐ వి ఎయిడ్స్ టీకాలు వేసే సమయం గా పేర్కొన్నారు.ఎయిడ్స్ నివారణ రక్షణ సంరక్షణ అంశాల పై అవగాహన కల్పించడం కార్యక్రమంలక్ష్యం.మనం ఎయిడ్స్ గుప్పెట్లో చిక్కకుండా ఉండాలంటే మనం అప్రమత్తంగా ఉండాల్సిన అవసరం ఉంది.లేదంటే అత్యంత భయంకరమైన ఎయిడ్స్ కు చిక్కినట్లే అని అంటున్నారు నిపుణులు. సురక్షిత మైన సంబంధాలు... రోగ నియంత్రణ, రోగాన్ని నిలువరించేందుకు సెంట్రల్ డ్రగ్ కంట్రోల్ అథారిటి సూచనల మేరకు కండోమ్ వాడకుంటే హెచ్ఐ వి అటు సంభోగసమయం లో అటు జననేన్డ్రియం యోని ఏనాల్ కు ఎయిడ్స్ సంక్రమించే అవకాసం ఉంది. అందుకే కండోం ఉపయోగించడం అత్యవసరం.మరో వైపు ఒరల్ సెక్స్ ద్వారా ఎయిడ్స్ సోకే ప్రమాదం అయినప్పటికీ దాని నుండి విముక్తి సాధ్యంకాదు వైరస్ శరీరం లోని అత్యంత సున్నితమైన వీర్య ద్రవం,యోని ద్రవం,రక్తంలో విస్తరిస్తుంది.లార్స్ ద్వారా మరిన్ని విషయాలు తెలుసుకోవాలి. పార్ట్ నర్స్ తల్లులకు హెచ్ ఐ వి పరీక్షలు... వైరస్ కేవలం పార్ట్ నర్స్ మధ్య మాత్రమే కాదు స్త్రీలు గర్భస్థ సమయం లో తల్లి పిల్ల మధ్య కూడా ఎయిడ్స్ వ్యాపించవచ్చు.ఒకవేళ తల్లికి సోకితే పిల్లకు తల్లిపాలు ఇవ్వరాదు.యోని ద్వారా ఇతర వ్యాధులు సోకితే హెచ్ ఐ వి వచ్చే ప్రమాదం ఉంది.అందుకే స్త్రీలు ఎస్ టి డి పరీక్షలు చేయించడం అవసరం. ఒకరి సూది మరొకరు వాడవద్దు... ప్రపంచ వ్యాప్తంగా ఎయిడ్స్ రోగుల సంఖ్య పెరుగుతున్న నేపధ్యం లోఎయిడ్స్ రోగులు వాడిన ఇతర వస్తువులు ముఖ్యంగా సూదులు వాడవద్దు.హెచ్ ఐ వి సూదుల ద్వారా సంక్రమించ వచ్చు.ఒకసూదిని మరొకరికి వాడడం వల్ల ఎయిడ్స్ సంక్రమించే అవకాసం ఉంటుంది.ఒకసూదిని స్టర్ లైజ్ చేసినప్పటికీ ముఖ్యంగా రక్త నమూనా సేకరణ,టాటూ వేసుకున్నప్పుడు.వాడే సూదులను వాడరాదని నిపుణులు సూచిస్తున్నారు. ఇలా ఒకరికి వాడిన సూదులను వాడరాడని.ఇంకొకరు వాడిన రె జర్లనువాడరాదని నిపుణులు అభిప్రాయ పడ్డారు.ఇలాంటి సిరంజులను,సూదులను పారేయడం మంచిదని నిపుణులు సూచిస్తున్నారు.వేరొకరికి వాడిన సూదిని మరలా వాడరాదని దీనిని అమలు చేస్తే హెచ్ ఐ వి సోకడం ఖాయ మని నిపుణులు పేర్కొన్నారు. ప్రోఫిలాక్సిన్ తో ఉపసమనం... ప్రోఫిలాక్సిన్ లేదా పి ఆర్ పి ఎవరు తీసుకోవాలంటే.ఎవరికైతే ఇంజక్షన్ ద్వారా లేదా సంభోగం ద్వారా మత్తుపదార్ధాలు ఇంజక్షన్ ఉపయోగించడం ద్వారా సోకే ప్రమాదం ఉందని నిపుణులు పేర్కొన్నారు.ప్రోఫెలాక్స్,లేదా పి డి పి ఇతర రెట్రో వైరల్ మందు ఎయిడ్స్ వచ్చే అవకాసం ఉందన్న విషయం గ్రహించినప్పుడు ప్రోఫెలక్స్ తీసుకోవచ్చని నిపుణులు సూచిస్తున్నారు. యాంటి వైరల్ చికిత్స... హెచ్ ఐ వి తగ్గిన తరువాత ఏ అర్ టి అంటే యాంటి రెట్రో వైరల్ తెరఫీ సూచిస్తారు.ఇది శరీరంలో వైరల్ లోడ్ ను తగ్గిస్తుంది.అది మిమ్మల్ని కొంతమేరా ఎయిడ్స్ నివారణ లో సహాయ పడుతుంది.గర్భస్థ సమయం లో తల్లిపాలు మాని సంభోగం లో పాల్గొన్నా,సిరంజీ ఇతరులతో పంచుకున్నా ఏ ఆర్ టి తీసుకున్న అది ప్రమాదం కావచ్చు.వ్యవహారికంగా ఏదైనా కావచ్చు.
read moreకాల్షియం అందించే ఆహారం...
వయస్సు పెరుగుతున్న కొద్ది ఎముకలు పటిష్టత తగ్గుతుంది.మీ ఎముకలు పటిష్టంగా ఆరోగ్యంగా ఉండాలంటే మీరు తీసుకునే ఆహారం లో 5 రకాల ఆహార పదార్ధాలను తప్పకుండా తీసుకోవడం ద్వారా కాల్షియం లోపాన్ని కొంత మేర నివారించవచ్చని నిపుణులు సూచిస్తున్నారు.వయస్సు పెరిగే కొద్ది శరీరంలో కాల్షియం తగ్గనివ్వకూడదు నిపుణుల సూచనలను పాటించండి. ఎముకలు,పళ్ళలో 99% కాల్షియం ఉంటుంది.శరీరంలో కాల్షియం ఉంటేనే ఇతర పనులు చేసేందుకు సహకరిస్తుంది.అందుకే ఎక్కువసార్లు ప్రతి నేలా పరీక్షలు నుర్వహిస్తూ ఉండాలి.అసలు శరీరంలో కాల్షియం లేక పోతే పోషక ఆహార లోపం కూడా ఉన్నట్టే. శరీరం లో కాల్షియం లోపిస్తే ఉండే లక్షణాలు ఇవే... 1 )ఎముకలలో నొప్పి బలహీనంగా ఉండడం. 2)కండరాలు పట్టు కుపోవడం. ౩ )కాళ్ళు,చేతులు తిమ్మిరి పట్టడం. 4)నడిచినప్పుడు అలసట లేదా నడవడం ఇబ్బందిగా ఉండవచ్చు. 5)స్త్రీలలో నెలసరి సమస్యలు. 6)పళ్ళు బలహీనంగా ఉండడం. కాల్షియం అందించే ఆహార పదార్ధాలు ఇవే... ఆకు కూరలు... ఆకు కూరలలో కాల్షియం పొందవచ్చు.కాల్షియం లోపాన్ని సవరించేందుకు ఆకు కూరలు తప్పనిసరిగా తీసుకోవాలి.ఆకు కూరలు తీసుకోవడం వల్ల ఎముకలు గట్టి పడడమే కాకుండా పెరుగు తాయి. పెరుగు... పెరుగు ఉత్తమ మైన ప్రోటీన్లలో పెరుగు ఒకటి. పెరుగులో ప్రోటీన్లు పుష్కలంగా ఉంటాయి.పెరుగు ద్వారా లభించే మంచి బ్యాక్టీరియా మనల్ని ఆరోగ్యంగా ఉంచుతుంది.మనం ఆరోగ్యంగా ఉండాలంటే 227 గ్రాముల పెరుగులో 4౦౦ మిల్లి గ్రాముల ప్రోటీన్ ఉంటుంది.పెరుగును అల్పాహారం గా తీసుకో వచ్చు. పన్నీర్... పన్నీర్ ద్వారా కాల్షియం లోపాన్ని తగ్గించ వచ్చు.పనీర్ లో పరిపూర్ణ మైన స్థాయిలో సంపూర్ణంగా కాల్షియం లభిస్తుంది.ప్రతిరోజూ పన్నీర్ దాదాపు 1౩౦ మిల్లి గ్రాములు కాల్షియం లభిస్తుంది. ఓట్స్... శరీరానికి కాల్షియం అందించాలంటే ఓట్స్ తీసుకోవడం చాలా మంచిది.ఓట్స్ తీసుకోవడం ద్వారా కాల్షియం లభిస్తుంది.ఒక కప్పు ఓట్స్ తినడం ద్వారా దాదాపు 1౦౦ నుండి 15౦ మిల్లిగ్రాముల కాల్షియం శరీరానికి అందించ వచ్చు.మీ శరీరానికి సంపూర్ణంగా కాల్షియం లభించడం వల్ల ఎముకలు కండరాలు పటిష్టంగా ఉంటాయి.
read moreఆరోగ్యంగా ఉండాలంటే!!
ఆధునిక దీర్ఘ కాలిక వ్యాధులను నయం చేయటానికి వ్యాధులను నయం చేయడానికి ఆరోగ్యం గా ఉండాలంటే,వ్యాధి నిరోధక శక్తికి ఆహార నియమాలు పాటిస్తే ఆరోగ్యంగా ఉండవచ్చు అంటున్నారు నిపుణులు ఆస్ట్రేలియన్ హెర్బల్ మెడిసిన్ కు చెందిన డాక్టర్ గుత్త లక్ష్మణ్ రావు.అసలు మనం దీర్ఘకాలిక అనారోగ్య సమస్యలు రాకుండా ఉండాలంటే సరైన ఆహార క్రమశిక్షణ తోనే సాధ్యం అని అంటున్నారు. ముఖ్యంగా శరీరాన్ని పట్టి పీడించే డయాబెటిస్,హై బిపి,గుండెసమస్యలు, అలసట, నీరసం,త్వరగా అలిసిపోవడం వంటి సమస్యలకు ప్రధాన కారణం శరీరానికి సరైన పోషకాలు అందక పోవడమే అని అంటున్నారు డాక్టర్ జి లక్ష్మణ్ రావు. ఇటీవల కాలం లో డాక్టర్ లక్ష్మణ్ రావు గారి నేతృత్వం లోని బృందం సమీకృత ఆహారం ఆరోగ్యం అన్న అంశం పై చేసిన పరిశోదన వివరలాను తెలుగు వన్ హెల్త్ కు వివరించారుమనం ఆరోగ్యంగా ఉండాలంటే మనం తీసుకోవాల్సిన ఆహార పదార్ధాలు ఏమిటి?. సంక్లిష్ట పిండి పదార్ధాలు... సంక్లిష్ట పిండి పదార్ధాలు అంటే తవుడు తీయని బియ్యము తవుడు తియ్యని ముడి బియ్యము అంటే పోలిష్ చేయనిముడి బియ్యము.తినాలి.గోధుమలు మీరే పిండి మర పట్టించి,జల్లెడ పట్టని గోధుమ పిండితో నూనెలేని పుల్కాలు ,రోటీలు చపాతీలు,చేసుకుని తినండి. బహు ధాన్యాలపిండి... గోధుమలు౩ కిలోలు,పచ్చ జొన్నలు,అరకిలో రాగులు,అరకిలో సజ్జలు అన్ని కలిపి పిండి పట్టించి జల్లెడ పట్టకుండా పుల్కాలు రోటీలు,చపాతీలు చేసుకోవచ్చు. పై మూడు రకాలు ప్రతి భోజనం లో ఉండాల్సిన అవసరం లేదు.ఒక్కో భోజనం లో ఒక్కో రకం వాడవచ్చు. కాయ కూరలు,ఆకు కూరలు... ప్రతి భోజనం లో ఒక కూర,ఒక ఆకు కూర ఉంటె మంచిది.మీరు ఆకు కూరలో పప్పు తినే అలవాటు ఉంటె మంచిది. మాంస కృ త్తులు... అంటే జంతు సంభంద మాంసకృత్తులకు బదులు శాఖా హారులు పప్పులను గింజలను వాడతారు.కంది పప్పు,పెసరపప్పు,సోయా పప్పు,గింజలను వాడతారు. కంది పప్పు,పెసర పప్పు,శెనగ పప్పు,ఉలవపప్పు,బటానీ పప్పు,కేసరి పప్పు,సోయా పప్పు,ఇలాంటివి జంతు సంబంధిత మాంస కృత్తులు కన్నా వీటిని జీర్ణించుకోవడం కష్టం.అజీర్తి గ్యాస్,ఎసిడిటి,కడుపు ఉబ్బరం,మల బద్ధకం,హేమరాయిడ్స్,పైల్స్,వంటి సమస్యలు ఉన్నవారికి ఏ రకమైన పప్పూ,పప్పులతో చేసిన పదార్ధాలు పనికి రావు.పరిస్థితులు మరింత దిగజారుస్తాయి.లేదా తీవ్రతర మౌతాయి,రోగి పరిస్థితిని బట్టి వైద్యుడు వీటి వాడకం తగ్గించమానో,పూర్తిగా వదిలివేయమానో చెప్పవచ్చు. ఊరాగాయ పచ్చళ్ళు... ఊరగాయపచ్చడి లేనిదే ఒక్క ముద్దకూడా దిగని తెలుగు వాళ్ళు లేరంటే ఆశ్చర్యం లేదు వీటి వాడకం తెలుగు ప్రజలలో ముఖ్యంగా కోస్తజిల్లాలలో విస్తారంగా పచ్చళ్ళు వినియోగిస్తారు.వీటిలో వేసే కారం కన్నా అధిక మోతాదులో వాడే ఉప్పు నూనె ఆరోగ్యానికి చాలా హానికరమైన పదార్ధాలు ,ఎండు మిరపకాయల కారం లో చాలా శక్తి వంత మైన ఔషద గుణాలు ఉన్నాయి.అయితే మిరప కయాల్ కారం లో మనం కలిపే ఉప్పు నూనె తదితర మసాలాలు దానిలోని ఔషద గుణాలు తటస్థం చేయడమే కాక మన గుండె రక్త నాళాల వ్యవస్థకు,కీళ్ళకు గణనీయం గా హాని కలిగిస్తాయి ఊర గాయ పచ్చళ్ళ ను ఎంత తక్కువగా వాడితే అంత మంచిది. పండ్ల రసాలు .... ఉదయము,మాధ్యాహ్నము,రాత్రి కూడా భోజనానికి 15 నిమిషాలు ముందు ఒక చిన్న గ్లాసు పండ్ల రసం తాగడం మంచిది.చాలా మందికి ఇది తప్పనిసరి. పండ్లు... ఉదయం భోజనానికి మధ్య భోజనానికి మధ్య,భోజనానికి మధ్య ,మాధ్యాహ్నం భోజనానికి రాత్రి భోజనానికి మధ్య పండు తినడం మంచిది.రోజూ ఒకే రకమైన పండు తినడం మంచిది.కాదు.ఒక్కో రకం పండ్లలో ఒకో రకం పోషకాలు ఉంటాయి.ఎన్ని రకాల పండ్లు తింటే అన్ని రకాల పోషకాలు శరీరానికి అందుతాయి. ఎండిన పండ్లు,పప్పులు... వీటిలో ఖనిజాలు,మాంస కృత్యాలు,తీపి పదార్ధాలు,విటమిన్లు ఎక్కువగా ఉంటాయి.ప్రతిరోజు వీటిని ఒక యాభై గ్రాములు తింటే మన జీర్ణ శక్తికి జీవన ప్రక్రియకు గ్రంధులు సమర్ధవంతంగా పనిచేయడానికి ఉపయోగ పడతాయి. గింజలు మొలకలు... గింజలలో కన్నా గింజల మొలకలలో మనకు ఉపయోగ పడే పోషకాలు అనేకరెట్లు ఎక్కువగా ఉంటాయి. అవి మనకు తేలికగా జీర్ణం అవుతాయి.మనం జీర్ణించుకున్న ఆహారం వేడిగా ను శక్తిగాను మార్చడానికి ఉపయోగపడతాయి.మొలకలలో ని పోషకపదార్ధాలు మనకు పూర్తిగా ఉపయోగ పడాలంటే మొలక నుండి వేరు ఒకటి,ఒకటి న్నార అంగుళం పొడవు పెరగాలి ఒకటి రెండు ఆకులు బయటికి వచ్చి ఆకు పచ్చరంగు కు మారాలి అలాంటి మొలకలనే తినాలి. పెర్మెంటెడ్ ఫుడ్స్... ఆంగ్లం లో మనము పెర్మెంటెడ్ ఫుడ్ అని పిలవబడే ఆహారపదార్ధలాను మనం తెలుగులో పులవ పెట్టిన ఆహార పదార్ధాలని చెప్పుకోవచ్చు.పెరుగు మజ్జిగ ఇలాంటివే వీటిలో ఉన్న కొన్ని సూక్ష్మ జీవులు సహజ ప్రక్రియ వల్ల పోషక విలువలు పెరుగుతాయి.తేలికగా జీర్ణం అవుతాయి. అత్యవసర కొవ్వు సంబంధిత ఆమ్లాలు... మన అర్రోగ్యం పటిష్టతకు కొవ్వు పదార్ధాలు అవసరం అయితే వాటిని అధికమోతాదులో వాడడం మన ఆరోగ్యానికి హానికరం అత్యవసర కొవ్వు సంబంధిత అమ్లాలలో ఒమేగా౩ ముఖ్యమైనది ఇది మన ఆహారం లో సరిపడా ఉండడం లేదు.ఇది అవిసగింజలలో ఫ్లాక్స్ సీడ్స్ లో పుష్కలంగా ఉంటాయి భోజనం కాగానే ఒక టేబుల్ స్పూన్ అవిశ గింజలు నమిలి తింటే ఆరోగ్యానికి మంచిది. పంచదారకు బదులు నల్ల బెల్లం... తెల్లని పంచదారలో కేవలం కేలరీలు తప్ప మరే ఇతర ప్రాధాన పోషక పదార్ధాలను గాని అధికంగా తినడం ఆరోగ్యానికి చాలా హానికరం అను అంటున్నారు ఆస్ట్రేలియన్ హెర్బల్ మెడిసిన్ కు చెందిన వైద్యులు డాక్టర్ జి లక్ష్మణ్ రావు గారు.చెరుకు పట్టించిన బెల్లం లో అనేక రకాల సూక్ష్మ పోషకపదార్ధాలు ఉనాయి.ఆరోగ్యానికి తేనె మంచిదని పరిశోధకులు చెపుతున్నారు.పంచదారకు బదులుగా నల్ల బెల్లం వాడడం మంచిదని సెలవిచారు. సముద్రపు ఉప్పు సైంధవ లవణం... నీటిలో ఉన్న ఖనిజాల పోషకాల విషయం లో సముద్రపు ఉప్పుకు ఇతర ఉప్పులకన్న చవక,అయితే దానిలో కొంచం చెమ్మ ఎక్కువగా ఉండడం తో సముద్రపు ఉప్పులో 84 రకాల ఖనిజాలు ఉన్నాయి మన రక్తం లో కూడా ఖనిజాలె ఆనిష్పత్తిలో ఉంటాయి.అవి మన గ్రంధులకు అవసరం మితంగా వాడినప్పుడు సముద్రపు ఉప్పు హై బ్లడ్ ప్రెషర్ కు దారి తీయదు.అని వంటకాల లోనూ సముద్రపు ఉప్పును వాడడం మంచిది. మంచి నీళ్ళు... ప్రతి రెండు గంటలకు ఒక గ్లాసు నీళ్ళు మన శరీరం లోని వ్యర్ధ పదార్ధాలను బహిష్కరించడానికి మన దేహంలో జరగాల్సిన అన్ని సహజ ప్రక్రియలకు అవసరమైన నీటిని అందించడానికి ఉపయోగ పడుతుంది. తిన కూడని పదార్ధాలు... తెల్లనిబియ్యము,తెల్లని గోధుమ పిండి,తెల్లని మల్టి గ్రెయిన్ పిండి,పంచదార. అన్నిరకాల తీపి పదార్ధాలు వేపుడు వంటకాలు.దుకాణాల లో అమ్మే తినుబండారాలు.మానడం మంచిది.మాంసం, గుడ్లు,చేపలు,రొయ్యలు,అన్నిరకాల పప్పులు పప్పులతో చేసిన వంటకాలు.రీఫైండ్ ఉప్పు,మసాలాలు,ఊరగాయ పచ్చళ్ళు,కాఫీ టీ,కూల్డ్రింక్స్. బౌతిక శ్వాస వ్యాయామం... ప్రతిరోజూ నడక,శ్వాస వ్యాయామం,భౌతిక వ్యాయామం అందరికీ అవసరం.ఎవయస్సులో ఉన్నవారైనా వ్యాయామం చేయడం అవసరం. రోజూ మన ఆహారం ఎలా ఉండాలి... ఉదయం పళ్ళు తోముకోగానే ఒకగ్లాసు క్యారెట్ జ్యూస్,బీట్ రూట్ జ్యుసే,మంచినీళ్ళు,ఉదయం అల్పాహారం,ఒక గ్లాసు పండ్లు,లేదా కాయ గూర,లేదా ఆకు కూర రసం, జల్లెడ పట్టని చిరు ధాన్యాలు,తృణ ధాన్యాల పిండితో నూనె లేకుండా కాల్చిన పుల్కాలు,కాయకూరల,ఆకుకూరల వేపుడు చేయని కూర,ఒక గ్లాసు చిక్కటి మజ్జిగ, ఒక కప్పు మీగడ లేని పెరుగు.అల్పాహారానికి,మాధ్యాహ్న భోజనానికి మద్ష్య మీఅకలిని బట్టి ఒకటి గాని రెండుకాని రకరకాల పండ్లు,తీసుకోవడం మంచిది. మాధ్యాహ్న భోజనం... ఒకగ్లాసు పండ్ల రసం,ముడి బియ్యం తో గంజి వార్చని అన్నం,ఒక కాయకూర,ఒక ఆకు కూరపప్పుఒక గ్లాసు చిక్కటి మజ్జిగ,ఒకకప్పు మీగడ లేని పెరుగు.ఫ్రూట్ సలాడ్,వేగితబుల్ సలాడ్,కాని తీసుకుంటే మంచిదని నిపునులు సూచిస్తున్నారు. మాధ్యాహ్న భోజనానికి,రాత్రి భోజనానికి మధ్య... మీ ఆకలిని బట్టి,ఒకటి లేదా రెండు రకాలపండ్లు,సాయంత్రం అయిదు గంటల మాధ్య ఒక యాభై గ్రాముల ఎండు పండ్లు,పప్పులు నట్స్ తీసుకోవడం మంచిది. రాత్రి భోజనం... ఒక గ్లాసు పండ్ల రసం ,మాధ్యాహ్న భోజనం కన్నా రాత్రి భోజనం తక్కువగాను,తేలికగానూ జీర్ణ మయ్యేవిధంగా జల్లెడ పట్టని మల్టి గ్రైన్ ఆటాతో చేసినపుల్కాలు కాయ కూర,లేదా ఆకు కూర,ఒక గ్లాసు మజ్జిగ,లేదా పెరుగు నిద్ర పోయే ముందుఒక కప్పు పాలు లేకుండా గ్రీన్ టీ లేదా హెర్బల్ టీ ఇది గాఢ నిద్ర పట్టేందుకు సహక రిస్తుంది.
read moreహై బిపి నిర్లక్ష్యం చేస్తే!!
హై పర్ టెన్ క్షణ్ డే సందర్భంగా ప్రత్యేక వ్యాసం. ఆదునికజీవన పరిణామ క్రమం లో నిత్య కృత్యంగా మారిపోయింది వయసుతో నిమిత్తం లేకుండా వచ్చే అనారోగ్య సమస్య బిపి అని అంటున్నారు నిపుణులు. కొన్ని దశాబ్దాల క్రితం కంటే ఈ రోజుల్లో హై బిపి సర్వసాధారణ మై పోయింది.ఈ పారిశ్రామికీకరణ,ఆధునికత హై టెక్ యుగం లో నిత్యజీవితం లో ఎదురయ్యే సమస్యలు అనేక ఒత్తిళ్ళు,వ్యక్తిగత అధిక బరువు,టే న్క్షన్స్,కొలస్ట్రాల్,డయాబెటిస్ మొదలైనవి హై బిపికి కారణ మౌతున్నాయి.దీర్ఘకాలిక. వ్యాదులైన ఆర్త్ఘరైటిస్,గుండె సంబంధిత సమస్యలు, డయాబెటిస్ వంటి వ్యాధులకు క్రమ శిక్షణ తో కూడిన ఆహారాన్ని తీసుకుంటే దీర్ఘకాలిక హై బిపి వంటి అనారోగ్య సమస్యలకు దూరంగా ఉండచ్చని నిపుణులు అంటున్నారు. ఒక్కహై బిపి హైపర్ టే న్క్షన్ తోనే ఎన్నోఅనారోగ్య సమస్యలు వస్తున్నాయని అంటున్నారు డాక్టర్ లక్ష్మణ్ రావు గారు.హై బి వచ్చిందో కిడ్నీ కి డ్యామేజ్ ఏర్పడుతుంది.హై బిపి వచ్చిందా గుండె పోటుకు దారితీస్తుంది,హై బిపి వచ్చిందా కంటి నరం దెబ్బ తింటుంది,హై బిపి వచ్చిందా మెదడు లో నరాలు దెబ్బ తింటాయి ఆపైన పక్షవాతం వస్తుంది ఇలా ఒక వ్యక్తిలో బిపి ని నియంత్రించకుంటే వచ్చే అనార్ధాలు ఇన్ని అన్ని కావని మొదటగా రోగి వెళ్ళిన వెంటనే డాక్టర్లు మొదటగా చూసేది బిపి మాత్రమే అంటే మన ఆరోగ్యాన్ని తీవ్రంగా ప్రభావితం చేసే హై బిపి ఎంత ప్రమాద కరమో అర్ధం చేసుకోవాలి అని అంటున్నారు నిపుణులు ఈమేరకు ప్రముఖ వైద్యులు మాట్లాడుతూ బిపి అందరికీ ఉంటుందని అయితే బిపి ఉందన్న సంగతి గుర్తించక పోవడ ఒక సమస్య అయితే బిపి ఉన్న వాళ్ళు తగిన జాగ్రతలు తీసుకోక పోవడం ఆందోళన కలిగిస్తుందని అంటున్నారు.బిపి ని నియంత్రించక పోవడం సరైన శ్రద్ధ తీసుకోకుంటే అది ప్రాణాంతకం అవుతుందని .అదీ కాక బిపి ని నియంత్రించడానికి అనేక అద్భుత మైన మందులు మార్కెట్లో లభిస్తాయి.కొంతమంది బిపి వచ్చిందని తెలిసినా డాక్టర్ ను కలవకుండా దానికి అదే తగ్గు తుందిలే అని నిర్లక్ష్యం చేస్తున్నారు. బిపి ని వైద్య పరి భాషలో... బిపి అంటే బ్లడ్ ప్రేషర్ అని మాత్రమే అనుకుంటారు శాస్త్రీయంగా సిస్టాలిక్ -డయాస్టాలిక్ బ్లడ్ ప్రెజర్ అని అంటారు.మన హృదయం అనుక్షణమూ రక్తనాళాల లోకి రక్తాన్ని పంప్ చెస్తూ ఉంటుంది.దేహానికి రక్తాన్ని సరఫరా చేస్తుంది.ఇలా రక్తాన్ని పంప్ చేయడానికి గుండె కుంచించుకు పోతుంది.అలా గుండె కుంచించుకు పోయినప్పుడే రక్తం గుండె నుండి రక్త నాళాల లోకి వేగంగా ప్రవహిస్తుంది.ఈ ఒత్తిడిని సిస్టాలిక్ బ్లడ్ ప్రెజర్ అని అంటారు. * గుండె తిరిగి సాధారణ స్థితికి వ్యాకోచించు కున్నప్పుడు ఏర్పడే రక్త స్థితిని డయా స్టాలిక్ బ్లడ్ ప్రెజర్ అంటారని నిపుణులు అంటున్నారు. *బిపిని పాదరసపు మిల్లీ మీటర్లలో కొలుస్తారు. ఉదాహరణకు బిపి లో సిస్టాలిక్ ప్రెజర్ -12౦. *డయాస్టాలిక్ ప్రెజర్ -8౦ రక్తపు సాధారణ స్థితి ఎలాఉంటుంది... *ఏ వయస్సులో అయినా రక్తపు సిస్టాలిక్ ప్రెజర్ 1౦౦ -14౦ మధ్య ఉండడం సాధారణ స్థితి. *కొందరు 9౦ వుండడం సాధారణ స్థితిగా అనుకుంటారు.అయితే ఒక్కోమనిషిలో ఒక్కోరకమైన రక్తపు సాధారణ స్థితిని గమనించవచ్చు.కొందరిలో వయసు పెరుగుతున్నకొద్దీ సిస్టాలిక్ ప్రెజర్ పెరుగుతూ ఉండడం గమనించ వచ్చు. *డయాస్టాలిక్ ప్రెజర్ మాత్రం ఏ వయస్సులో అయినా రావచ్చు.6౦ -9౦ మధ్య ఉండడం సాదర స్థితిగా వైద్యులు పేర్కొన్నారు. *సహజంగా పరిశీలిస్తే వ్యక్తిలో రక్తపోటు ఉదయం నుంచి సాయంత్రానికి మారిపోతుంది.ఉదయపు వేళల్లో తక్కువ వత్తిడి ఉంటుంది.పగటి పూట పనుల్లో అలిసి పోయి ఉండడం తో సాయంత్రానికి ఎక్కువ వత్తిడి ఉంటుంది.ఒక వ్యక్తిలోని కోపతాపాలు,ఆవేశ కావేశాలు,ఆయా పరిస్థితులలో ఎదురయ్యే సంఘటనల ఆధారంగా ఉద్రేకం,ఆందోళన,భయం,వంటివి మనిషిలో బిపి ని పెంచుతాయి.ఎమోషన్స్ సాధారణ స్థాయికి రాగానే బిపి కూడా మళ్ళీ సాధారణ స్థితికి వచ్చేస్తుంది. *ముఖ్యమైన విషయం ఏమిటి అంటే కొన్ని కొన్ని ప్రత్యేక సందర్భాలలో బిపి ఎక్కువగా చూపినంత మాత్రాన అది బిపి కిందకు రాదు.నాలుగు ఇదు సార్లు వేరు వేరు రోజుల్లో బిపి ని చెక్ చేసుకోవాలి అన్ని సార్లు ఎక్కువే వస్తుంటే మాత్రం దానిని హై బిపి కింద తీసుకో వచ్చ్గు. హై పేర టెన్క్షణ్... హై బిపి మరీ అసాధారణం గా పెరిగి పోతే దానిని హై పర్ టెన్క్షణ్ అని అంటారు.మానసికంగా శారీరకంగా ఒత్తిడి గురియినప్పుడు బిపి హై పర్ టెన్క్షణ్ కి దారి తీస్తుంది.అయితే హైపర్ టెన్ క్షణ్ తో బాధ పడే వ్యక్తికి ఏ వత్తిడి లూ లేని సాధారణ స్థితిలో కూడా బిపి పెరగడానికి అవకాశాలు ఉన్నాయి. చాలా మంది తమకు హై పర్ టెన్క్షణ్ ఉందని తెలియకుండానే దానితో బాధపడుతూ సడన్ గా గుండె పోటు కో,పక్ష వాతానికో గురికావడాన్ని గమనించవచ్చు అయితే ఒక వయసుదటాక రెగ్యులర్ గా మెడికల్ చకప్ చేయించుకోవడం అవసరం.హై పర్ టెన్క్షణ్ స్త్రీల కంటే పురుషులలో అధికంగా ఉంటుంది అలాగే మధ్య వయస్సు లో ఉన్నవారికి,వయస్సు మళ్ళిన వాళ్ళలో అత్యధికంగా ఉంటుంది.చెప్పుకోదగ్గ రీతిలో యుక్త వయస్కులలో కూడా తరచుగా కనిపిస్తోంది. హై బిపి ని నియంత్రిన్చాకుంటే ప్రమాదమే .... హై బిపి నిర్ధారణ అయ్యిన తరువాత ఏ మాత్రం నిర్లక్ష్యం చేసినా వచ్చే అనార్ధాలు ఇవే... ఆయుషు తగ్గుతుంది ... హై బి పి ని సక్రమంగా నియంత్రించుకొకుంటే ఆవ్యక్తి ఆయుష్షు తగ్గిపోత్తుంది.సాక్ష్యాధారాలు ఉన్నాయని నిపుణులు అంటున్నారు.బిపి ని నియంత్రించుకోకుంటే అర్ధంతరంగా 16 సంవత్సరాల ముందుగానే చనిపోతారు. 45 -55 సంవత్సరాల వయస్సుకల వారిలో 6 --11సంవత్సరాల లోపు చనిపోయిన దాకలాలు ఉన్నాయి. గుండె పెరుగుతుంది... హై బి పి ఉన్న వ్యక్తి రక్త నాళాల లో కి రక్తం అధిక పీడనం తో ప్రవహించడం వల్ల గుండె మీద అధిక బారం పడి రక్తాన్ని పంప్ చేయడం గుండె ఎక్కువ శ్రమ పడాల్సి వస్తుంది.ఆక్రమం లో ఆ వ్వ్యక్తిగుండె బాగా పెరిగి ఇక ఏ మాత్రం ఒత్తిడిని తట్టుకోలేక రక్త ప్రసారం సామార్ధ్యం కోల్పోతుంది. కోరోనరీ ధమని వ్యాధి... హై బిపి మూలంగా చివరికి కోరోనరీ ధమనులు ఇరుకుగా అయి పోయి అది యంజైనా కి గుండె పోటు కీ దారి తీస్తుంది. బ్రెయిన్ హేమరేజ్... రక్త పోటు తీవ్రత వల్ల మెదడులోని రక్త నాళం చిట్లి రక్త స్రావం జరిగి ఆ వ్యక్తి మృత్యువును చేరుకోవచ్చు.లేదా మెదడు డ్యామేజ్ అవకాశం ఉంది అని హెచ్చరిస్తున్నారు వైద్యులు. పక్షవాతం... రక్త పీడనం మాటి మాటికి పెరగడం వల్ల కొన్నాళ్ళకు మెదడుకు రక్తాన్ని చేర వేసే నాళాలు ఇరుకుగా అయి మూసుకు పోయి త్రంబోసిస్ పెరాలసిస్ వంటి అనారోగ్యం దీర్ఘకాలిక అనారోగ్యం శాశ్వత అంగవైకల్యం రావచ్చు. కంటికి అనార్ధాలు... హై బిపి మూలంగా కంటి వెనుక ఉండే నరం ఉబ్బడం లేక చిట్లడం జరిగి ఎదుటి దృశ్యాలు అల్లుకు పోయినట్లుగా కనిపించి కాల క్రమం లో కంటి చూపు కోల్పోయే ప్రమాదం ఉంది కంటి రక్త సరఫరా చేసే నరం పూర్తిగా మూసుకు పోయి అకస్మాతుగా అంధత్వానికి దారి తీయ వచ్చు. హై బిపి తలనొప్పి ... హై బి పి మరీ తీవ్రమై నప్పుడు మెదడులోని ధమనులు బిగుసుకు పోయి లేదా మెదడు వాపు చెంది దానిఫలితంగా తీవ్రమైన తల నొప్పి తాత్కాలికంగా చూపు తగ్గిపోవడం మాటలు తడబడడం ఒక్కోసారి ఫైట్స్ కూడా రావచ్చు. కిడ్నీ ఫైల్యూర్.... హై బిపి ని నిర్లక్ష్యం చేసి చికిత్చ తీసుకోకుంటే కిడ్నీలు పాడయ్యే అవకాశం ఉందని.పగాలే కాక రాత్రి కూడా మూత్రానికి వెళ్ళడం అతని కిడ్నీలు పది శరీరం నుండి తోక్సికేంట్స్ నిల్వ పెరగడం మొదలుఅవుతుంది.
read moreకోవిడ్ 19లో మరణాలు ఎన్నో తెలుసా...?
2౦2౦-2౦ 21 లో కోవిడ్ ధాటికి ప్రపంచ వ్యాప్తంగా 14.9 మిలియన్ల ప్రజల ప్రాణాలు గాలిలో కలిసి పోయాయి. అని ప్రపంచ ఆరోగ్య సంస్థ వెల్లడించింది. కోవిడ్19 ప్యాండమిక్ అంతులేని విషాదం మిగిల్చినదని ప్రపంచ ఆరోగ్య సంస్థ విడుదల చేసిన వివరాల ప్రకారం 14.9 మిలియన్ల మిలియన్ల ప్రజలు మరనినిచినట్లు డబ్ల్యు హెచ్ ఓ వెల్లడించింది. ప్రత్యక్షంగా పరోక్షంగా కరోనా వైరస్ జనవరి2౦2౦ డిసెంబర్ 2౦21 లో డబ్ల్యు హెచ్ ఓ చేసిన పరిశోదనలో కోవిడ్ మరణాలను చేర్చింది.వైద్య చికిత్సలు సత్వరం అందక పోవడం వల్ల ప్యాండమిక్ లో ఆరోగ్య వ్యవస్థ పై పెను భారం పడిందని నిపుణులు అంచనా వేస్తున్నారు.కోవిడ్ తో పాటు మరిన్ని అనారోగ్య సమస్యలు చుట్టు ముట్టాయి.కోవిడ్ ప్రత్యక్షంగా పరోక్షంగా నేరుగా మరణాలకు కారణమై నట్లు ప్రపంచ ఆరోగ్యసంస్థ వెల్లడించింది. రెండేళ్ళ కాలం లో 1౩.౩ మిలియన్ల --16.6 మిలియన్ల మరణాలు ఉండవచ్చని అంచనా.చాలా మంది నిపుణులు మరణాల సంఖ్య లెక్క లేన్నంత ఉందని తె లిపారు. అంటే6.2 మికియన్లు గా ఉండవచ్చని.జోన్ హాప్ కిన్స్ యునివర్సిటి పరిశోదనలో మరణాలకు కారణం వైరస్ అని తేల్చారు. ఈ సమాచారం కేవలం ప్యాండమిక్ ప్రభావం అన్నిదేశాలకు ఉపయోగ పడగలదని ఆరోగ్యం తమ తమ ఆరోగ్య విధానాల పై పెట్టుబడులు పెట్టాల్సిన అవసరం ఉందని తీవ్ర ఇబ్బందులలో అత్యవసర సేవలు అందించడం లో బలీయంగా ఉన్న ఆరోగ్య సమాచారం అందించేందుకు దోహదం చేస్తుందని డబ్ల్యు హెచ్ ఓ డైరెక్టర్ జనరల్ టేడ్రోస్ అద్నాం గాబ్రియోసిస్ ఒక ప్రకటనలో తెలిపారు. డబ్ల్యు హెచ్ ఓ అన్ని దేశాలతో కలిసి పనిచేసేందుకు సిద్ధంగా ఉందని.ఆయా దేశాల ఆరోగ్య సమాచారం సరైన నిర్ణయం బలో పేతం చేసుకోవాలని సరైన సమాచారం సరైన నిరయం వల్ల మంచి ఫలితాలు వస్తాయని అన్నారు. దక్షిణ ఆశియాలో ని యురప్,అమెరిక లో84% అదనపు మరణాలు జరిగాయని డబ్ల్యు హెచ్ ఓ తెలిపింది. డబ్ల్యు హెచ్ ఓ ప్రకటనలో 68% అదనపు మరణాలు1౦ దేశాలలో యు ఎస్ లో మరణాల సంఖ్య 57% కాగా 4౩% స్త్రీలు ఉన్నట్లు సమాచారం.స్టాట్ సమాచారం ప్రకారం 2౦21 నాటికి ఒక మిలియన్ ప్రజలు కోవిడ్ వల్ల మరణించారు.1౩%కన్నా ఎక్కువె జహన్ హాప్కిన్స్ లెక్కల ప్రకారం యు ఎస్ లో 9,96,౦౦౦ మరణించగా న్యూఇయర్ కు నాలుగు నెలల ముందుగా మరణించడం విచారకరమని అని డబ్ల్యు హెచ్ ఓ పేర్కొంది. ఎస్ స్టాట్ లెక్కల ప్రకారం భారత్ లో 2౦2౦ లో 481,౦౦౦ మరణించినట్లు తెలిపింది.అదనంగా 4,75,౦౦౦ మరణాలు 2౦2౦ నాటికి ఎంతమంది మరణించారో దేనివల్ల చనిపోయారు అన్నది చెప్పలేదు.ప్రస్తుతం ఉన్న లెక్కలు ఇంకా పూర్తిగా లేక్కిన్చాల్సి ఉందని.లేక్క్హల సంఖ్యను చూసినప్పుడు భవిష్యత్తులో ఇలాంటి ఉపద్రవాలను ఎదుర్కోవాలి? ఎలాస్పందించాలి అని యాలె స్కూల్ పబ్లిక్ హెల్త్ కు చెందినా ఇన్ఫెక్షన్ వ్యాధుల నిపుణుడు ఆల్బర్ట్ డబ్ల్యు హెచ్ ఓ నిర్వహించిన పరిసీలనలో పాల్గొన్నారు ఈంశాన్ని మీడియా సమావేశం లో వెల్లడించడం గమనార్హం.
read moreసిస్టర్… నీకు వందనం..
నాణ్యత తో కూడిన వైద్యం అందించడం లో కీలక పాత్ర నర్సులదే... నర్సుల సేవలు నిరుపమానం... ప్రపంచ నర్సింగ్ దినోత్సవం సందర్భంగా ప్రతీఏటా లేడీ ఆఫ్ నైటింగేల్ జన్మ దినోత్సవం జరుపుకుంటున్నారు. ప్రపంచ వ్యాప్త్గంగా యుద్ధ మేఘాలు కమ్ముకున్న వేళ ఆయుద్ధం లో కొనఊపిరి తో కొట్టు మిట్టడుతున్న వారికి సైనికుల కు వైద్య సేవలు అందిస్తూ వైద్యరంగం లో నర్సింగ్ చేయడానికి కొన్ని సందర్భాలలో కులం, మతం, బీద, ధనిక అన్న బేదం లేదు. కేవలం అస్వస్థత తో ఉన్నవారికి స్వస్థత చేకుర్చాలి అన్నదే లక్ష్యం గా నర్సింగ్ లక్ష్యం. అడిసగా లేడీ అఫ్ డి నైటింగెయిల్ గా ఆమె సేవలు నేటికి చిరస్మరణీయంగా స్ఫూర్తి దాయకంగా నాణ్యతతో కూడిన వైద్యం అందించడంలో నర్సులదే కీలక పాత్ర. ఇక్కడ మనం చర్చించాల్సిన అంశం, గుర్తిం చాల్సిన అంశం ఏమిటి అంటే కోవిడ్19 తరువాత భవిష్యతు లో ఎలా ఉండాలో ఎలా ఉండాల్సి వస్తుందో అప్రమత్తం చేసింది. మనకు ఎన్నో గుణపాటాలు నేర్పింది.ఆరోగ్య విధానం లో మార్పులు తచ్చింది. నర్సింగ్ వృత్తికి గుర్తింపు స్వయం కృషితో ఎదిగేందుకు 2౦22 ఆరోగ్య సంరక్షణ పై దృష్టి పెట్టాల్సిన అవసరం వివరించింది. 2౦22 ప్రపంచ నర్సింగ్ దినోత్సవం సందర్భంగా ముందుకు నడవాలంటే మీ స్వరాన్ని వినిపించేందుకు నర్సులు ముందుకు రావాలి ఎందుకంటే ఫ్రంట్ లైన్ వర్కర్స్ గా కోవిడ్ సమయంలో వారు అందించ్గిన సేవలు నిరుపమానం శ్లాఘనీయం.ఆ సేవలు ఎన్నటికీ వెలకట్ట లేనివి. భయంకరమైన కోవిడ్ మహమ్మారి విలయ తాండవం చేస్తున్న వేళ మిలియన్ల ప్రజల ప్రాణాలుజీవితాలను రక్షించి ప్రాణాలు కాపాడెం దుకు సవాళ్ళను ఎదుర్కుంటూనే తమ కుటుంబాల సైతం ఫణం గా పెట్టి సరైన సమయం లో మందులు అందిస్తూ రోగులు త్వరగా కోలుకోవడం లో కీలక పాత్ర పోషించేది మేడికల్ మ్యానేజ్ మెంట్ కీలకం.ముఖ్యంగా కోరోనా సమయం లో ఎన్నోసవాళ్ళను అధిగమిస్తూ ఎదురొడ్డి పోరాడిన నర్సులుఅందరికీ తెలుగు వన్ హెల్త్ సెల్యూట్ చేస్తుంది. కోరోనా చికిత్స అనంతరం కూడా కేంద్రం అందించిన వ్యాక్సినేషన్ కార్యక్రమాన్ని విజయవంతం గా పూర్తి చేయడం లో నర్సులదే కీలక భూమిక పోషించారు.ముఖ్యంగా మారుమూల గ్రామీణ ప్రాంతం లో సైతం వ్యాక్సిన్ అందించడం లో కీలక పాత్ర పోషించింది నర్సులే. ప్యాండమిక్ సమయం లో సరైన వైద్యం సరైన మందు అందించినప్పటికీ ఆయాదేశాలలో నర్సుల కొరత తీవ్రంగా ఉంది.అని ప్రపంచ ఆరోగ్య సంస్థ పేర్కొంది.2౦ 24 నాటికి భారత దేశం లో 4౩౦ మిలియన్లకు పైగా నర్సులు అవసరమని ముఖ్యంగా రానున్నరోజుల్లో ప్రజా ఆరోగ్యం పై సవాళ్ళను ఎదుర్కునేందుకు అవసరమని ప్రత్యేక మైన సవాళ్ళు ఎదురయ్యే నేపధ్యం లో నాణ్యత తో కూడిన వైద్య సేవలు అందించడం అవసరం ఎదురయ్యే రోగాలనుండి రోగులను సంరక్షించడం అవసరం. నర్సింగ్ సమస్యలు... కోవిడ్ వచ్చి మూడు సంవత్సరాలు గడుస్తోంది.కోవిడ్ సమయంలో కోవిడ్ రోగులకు కొన్ని మందులు ఇచ్చే సమయం లో అమ్మిన మందులు అందులో కొన్ని మందులు నాణ్యత లేకపోవడం ఉదాహరణకు రేమిడి సివిర్,మాలో పెరవిర్ వంటి మందులు సైతం అత్యవసర సమయం లో పనికి వస్తాయంటూ అందులోనూ డూప్లికేట్ మందులు లక్షల రూపాయలకు అమ్ముకున్నారు ఈ అంశాలను సైతం నర్సింగ్ చేసే నర్సులు గమనించాలి.నర్సింగ్ విధానాన్ని పూర్తి స్వేచ్చగా వ్యవహరించే వెసులు బాటును కల్పించాలి.ఆరోగ్య సంరక్షణ సవాళ్ళను ఎదుర్కోవాలంటే నిర్మాణాత్మక మార్పులు ప్రవేసపెట్టాలని నాణ్యతతో కూడిన వైద్యం అందించడం లో నర్సులదే కీలక పాత్ర నర్సింగ్ సేవలు అందించే వారికి ప్రోత్సాహకాలు విలువైన నాణ్యతతో కూడిన మందుల పంపిణీ అవసరం. ఒక్క పురుగు మొత్తం పంటను నాశనం చేసినట్లు ఒకసారి వైద్యరంగం లో మెరుగైన సేవలు అందించకుంటే అసేవకు విలువ ఉండదు.
read moreవిటమిన్ డి లోపానికి కారణాలేంటి ?
విటమిన్ డి లోపం వల్ల మన శరీరం లోని ఎముకలు. మేత్తబదిపోతాయి. మెల్లిగా పట్టుకోల్పోతాయి . అలాగే ఎముకల లో కాల్షియం లోపం వల్ల ఆస్టియో ప్రోరో సిస్ వంటి సమస్యలు మొదలై ఎముకలలో పట్టుకోల్పోవడం కుప్పకూలిపోవడం వంటి సమస్యలు వస్తాయి. ఈ సమస్యనుండి బయట పడేందుకు ఐదు రకాల ఆహార పదార్ధాలు అందినప్పుడే మన ఆరోగ్యాన్ని పరిరక్షించడం లో కీలక పాత్ర పోషిస్తాయి.అలా చేయనట్లైతే మరెన్నో సమస్యలు సృష్టిస్తుంది. నేడు మనం విటమిన్ డి గురించి మాట్లాడుతున్నాము.విటమిన్ డి తగ్గుదల కారణంగా ఏమౌతుంది డి విటమిన్ కొరతను ఎలా అధిగమించవచ్చు. విటమిన్ డి ఎప్పుడు తగ్గుతుంది.అంటే శరీరానికి అవసరమైన మేర సూర్యరస్మి లేదా ఆహారం లో విటమిన్ డి లభించదో అప్పుడు అప్పుడు విటమిన్ డి విటమిన్ డి లోపం కారణంగా అప్పుడు విటమిన్ డి లోపం కారణం గా ఎముకలు పట్టుకోల్పోతాయి. బలహీన పడి పోయి ఆస్టియో ప్రోరో సిస్ వంటి సమస్యలు వస్తాయి.ఎముకలు నెమ్మదిగా విరగడం.లేదా పొడి రాలిపోవడం వంటి సమస్యలుఉన్నట్లు గుర్తిస్తారు. విటమిన్ డి ను సన్ షైన్ విటమిన్ బి కూడా అంటారు.ఎందుకంటే మీశరీరం లో ని కొలస్ట్రాల్ ద్వారా తయారు అవుతుంది. అప్పుడు మీచర్మం సూర్యకిరణాలు అనుసంధానం చేయడం ద్వారా విటమిన్ డి కోవిడ్19 మహమ్మారి కారణంగా కొంతకాలం గా చర్చ నీయంశం అయ్యింది. దీనికితోడు చర్మ సంరక్షణ ఆరోగ్యంగా ఉండేందుకు దోహదం చేస్తుంది.ఇది ఎముకల పటిష్ట తకు ఆరోగ్యంగా ఉండేందుకు శరీరం లోని పలు విభాగాలు సరిగా పనిచేసేందుకు బాధ్యత వహిస్తుంది. అలాగని మీ శరీరంలో విటమిన్ డి తగ్గినట్లితే ఆరోగ్యం ప్రమాదం లో పడే అవకాసం ఉందని వైద్యులు అంటున్నారు. విటమిన్ డి లోపం వల్ల మీ జాయింట్స్ లో నొప్పులు పొట్టలో నొప్పి తో పాటు కండరాల నొప్పులు సమస్యలు వస్తాయి. విటమిన్ డి లోపం ఉండే వాళ్ళ లక్షణాలు... ఎల్లప్పుడూ అలిసిపోయినట్లుగా అనిపించడం. ఎముకలలో నొప్పులు. నడుము నొప్పులు. బలహీనంగా ఉన్నట్లు అనిపించడం. గాయం లేదా చిన్న చిన్న దెబ్బలు త్వరగా తగ్గక పోవడం. ఎల్లప్పుడూ ఒత్తిడిలో ఉండడం. జుట్టు ఊడిపోవడం వంటి లక్షణాలు ఉంటాయి. విటమిన్ డి ఎందుకు లోపిస్తుంది? మీరు తీసుకున్నే ఆహారం శరీర వ్యాయామం లేదా ముఖ్యంగా మీరు తీసుకునే ఆహారం లో లోపాల కారణంకాగా మీజీవన శైలి కారణంగా శరీరం లో విటమిన్ డి లోపిస్తుంది. మీరు తీసుకునే ఆహారం విషయం లో సరిగా వ్యవహరించాకుంటే పోషక తత్వాలలోపం ఏర్పడు తుంది. విటమిన్ డి లోపం ఎలా భర్తీ చేయాలి... మీ శరీరం లో విటమిన్ డి లోపిస్తే డాక్టర్ మిమ్మల్ని విటమిన్ డి సప్లిమెంట్స్ తీసుకోవాలని సూచిస్తారు.దీనికితోడు అదీకాక మీరు ఆహారం లో ఈ ఆహార పదార్ధాలను చేర్చడం తప్పని సరి. విటమున్ బి సంపూర్ణంగా లభించే ఆహారం ఇవె... సోయాబీన్... సోయాబీన్ లో విటమిన్ డి తో పాటు,ప్రోటీన్,కాల్షియం,ఒమేగా ౩,ఫ్యాటియాసిడ్స్,ఐరన్,విటమిన్ బి జింక్,ఫోలేట్,సెలీనియం, వంటి పోషక తాత్వాలు ఉంటాయి.వీటిని తీసుకో వడం వల్ల ఆస్టియో ప్రోరొ సిస్ వల్ల వచ్చే ప్రమాదాన్ని తగ్గించ వచ్చు. పన్నీర్... పన్నీర్ లో కాల్షియం తో పాటు విటమిన్ డి పుష్కలంగా ఉంటుంది.దీనిని తీసుకోవడం వల్ల కేవలం ఎముకలు మాత్రమే కాదు కండరాలు పుష్కలంగా ఉంటాయి. పాలక్... పచ్చటి ఆకుకూరలలో పాలకూర తప్పని సరిగా తీసుకోవాలి శరీరం లో విటమిన్ డి సంపూర్ణంగా లభిస్తుంది.శరీరానికి చాలా రకాల పోషక తత్వాలు ఇస్తుంది. గుడ్డు... విటమిన్ డి లోపాన్ని భర్తీచేయాలంటే గుడ్డు తప్పనిసరిగా తినాలి.గుడ్డులో విటమిన్ డి కాల్షియం చాలా రకాల పోషక తత్వాలు ఉంటాయి. పాలు... పాలలో కాల్షియం తో పాటు విటమిన్ డి పుష్కలంగా లభిస్తుంది.విటమిన్ డి లోపం అధిగమించేందుకు రోజూ పాలు తాగాలి. ఐదు రకాల పద్దర్ధాలు విటమిన్ డి లోపం నుండి మిమ్మల్ని రక్షిస్తుంది మిమ్మల్ని ఆరోగ్యవంతులని చేస్తుంది.
read more